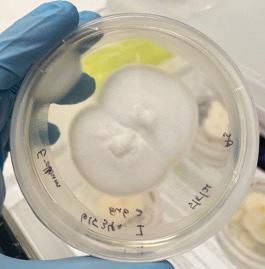
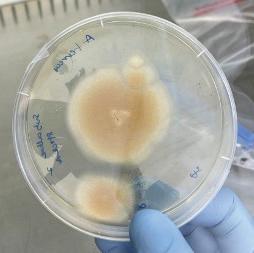

Beyond thirty
Wastech CEO Clete Elms has a clear vision to transform the company into a national entity for waste solutions.

FEATURES
Tour of duty
Calcuated risks
Grinding in the Top End
New hope for mining waste
PROUDLY SUPPORTED BY:

AUGUST 2023
PMS 380 PMS 376 PMS 355












COVER STORY 20
BEYOND THIRTY
Australian manufacturing company
Wastech marks a major milestone and sets a vision statement for the future.
46
WOMEN IN INDUSTRY
Student
“WASTECH SEES A REAL OPPORTUNITY TO BECOME
SUSTAINABILITY EXPERTS THROUGH TECHNOLOGY AND INDUSTRY INNOVATION.”
- Clete Elms, Chief Executive Officer, Wastech
In this issue
Features
32 CHEMICAL BROTHERS
DAF trucks helps keep Unanderra Tanker Hire, a leader in chemical transportation, on the road.
34 RESOURCES RECLAIMED
National Resource Recovery leverages a growing demand for hazardous waste solutions.
36 NO FIRE OR FLAMES
FLIR explains the benefits of thermal imaging cameras to help prevent fires.
38 GRINDING IN THE TOP END
When home is 700 kilometres away, Komatsu Forest helps get things done.
40
NOT THE STANDARD FARE
National Transport Research Organisation helps increase the use of recycled materials.
42 SWITCH IT UP
44 REDEFINE RELIABILITY
Caterpillar boosts machine performance and reliability in an already robost landfill compactor.
46 TAIL’S END
A winner at this year’s Women in Industry Awards, Ashara Moore aims to make the mining sector ‘better’.

48 WASTE WATCHDOGS
Victoria’s leading waste regulators come together for an industry breakfast at Waste Expo 2023.
51 BUILDING MOMENTUM
The inaugural 2023 Inside Construction Expo is taking shape.
52 COUNCIL IN FOCUS
Bayside Council New South Wales adds another award to its collection.
Regulars
54 PRODUCT SPOTLIGHT
WestRex
ALLU buckets keep recycling and resource recovery operations one step ahead.
57 LAST WORD

12 HUNGRY FUNGI Researchers discover strains of fungi that could offer a solution to help break down Polypropylene. 15 INDUSTRY INSIGHT Tony Khoury reflects on more than 30 years in the waste and resource recovery industry. 18 THE BREAKDOWN Industry leaders have their say on current issues. 20 COVER STORY Wastech Engineering sets a course for beyond 30. 24 GLOBAL RECOGNITION Water & Carbon Group technology is achieving success in leachate treatment around the world. 26 CHARGING AHEAD E-waste recycler Ecocycle prepares for a massive increase in EV battery waste. 29 CALCULATED RISK
provides sustainable solutions to a niche market.
awarded for research that could positively impact mining’s greenhouse-gas emission targets.
4 / WMR / August 2023

Call: Email: Visit: 03 9706 8066 sales@appliedmachinery.com.au appliedmachinery.com.au genoxmachinery.com.au At Applied, our number one priority is ensuring that our customers across the country get the machinery they need, with the support they expect. With nearly 30 years’ experience, and thousands of satisfied customers across the country we’re here for the long term. We’re a true machinery partner – just ask Steve Morriss. Real Service. Real Support. Real People. That’s Applied Thinking.
ISSUE IS FIXED STRAIGHT
THAT’S
“ANY
AWAY.
THE BENEFIT OF A LOCAL SUPPLIER WITH FULL TECHNICAL SUPPORT AND BACK-UP.” STEVE MORRISS, CLOSE THE LOOP, SOMERTON, VIC
From the Editor
Handle with care
Lithium-ion batteries have found their way into common household devices from mobile phones and laptops, to e-bikes and e-scooters.
Recent research suggests an increasing uptake in electric vehicles (EV), driven by environmental and cost benefits, will mean Australia is left with up to 30,000 tonnes of end-of-life EV batteries by 2030.
The numbers alone are concerning, but it’s exacerbated when you consider Australia doesn’t yet have the capacity or infrastructure to safely handle that number of end-of-life EV batteries.
In Melbourne, e-waste recycler Ecocycle is on the front foot, investing millions into transportation devices and technology to safely strip back and recycle battery components.
Zoltan Sekula, Product Stewardship Manager, says it’s too late to shut the gate once the horse has bolted. In this edition of Waste Management Review, Sekula outlines the lengths the company has gone to in preparation for the influx.
It’s not just batteries that require a specialist approach. Hazardous waste continues to grow faster than other waste streams in Australia. Tighter regulatory controls and community expectations add complexity to an already dangerous situation.
As this edition highlights, Australia is rich in industry experts who have pivoted their business to maximise resource recovery from wastes that were previously destined for landfill.
Our cover story is also an example of a company leveraging its expertise to take it into the future. As Wastech marks a 30-year milestone it’s asking the question –what does 30 and beyond look like? Recently appointed Chief Executive Officer Clete Elms provides a glimpse into the company’s future.
And when it comes to the future, the industry is in good hands. Ashara Moore, winner of the Excellence in Mining award at the recent Women in Industry Awards, takes us through her work to find a more sustainable solution for tailings waste.

Happy reading
Lisa Korycki
CHIEF OPERATING OFFICER
Christine Clancy christine.clancy@primecreative.com.au
GROUP MANAGING EDITOR
Sarah Baker sarah.baker@primecreative.com.au
MANAGING EDITOR
Mike Wheeler mike.wheeler@primecreative.com.au
EDITOR
Lisa Korycki lisa.korycki@primecreative.com.au
JOURNALIST
Chris Edwards chris.edwards@primecreative.com.au
DESIGN PRODUCTION MANAGER
Michelle Weston michelle.weston@primecreative.com.au
ART DIRECTOR
Blake Storey blake.storey@primecreative.com.au
DESIGN
Louis Romero, Kerry Pert
BRAND MANAGER
Chelsea Daniel chelsea.daniel@primecreative.com.au
p: +61 425 699 878
CLIENT SUCCESS MANAGER
Justine Nardone justine.nardone@primecreative.com.au
ACCOUNT CO-ORDINATOR Marina Milisavljevic marina.milisavljevic@primecreative.com.au
HEAD OFFICE
Prime Creative Pty Ltd 379 Docklands Drive Docklands VIC 3008 Australia p: +61 3 9690 8766 f: +61 3 9682 0044 enquiries@primecreative.com.au www.wastemanagementreview.com.au
SUBSCRIPTIONS
+61 3 9690 8766 subscriptions@primecreative.com.au
Waste Management Review is available by subscription from the publisher. The rights of refusal are reserved by the publisher
ARTICLES
All articles submitted for publication become the property of the publisher. The Editor reserves the right to adjust any article to conform with the magazine format.
COPYRIGHT

Waste Management Review is owned by Prime Creative Media and published by John Murphy.
All material in Waste Management Review is copyright and no part may be reproduced or copied in any form or by any means (graphic, electronic or mechanical including information and retrieval systems) without written permission of the publisher. The Editor welcomes contributions but reserves the right to accept or reject any material. While every effort has been made to ensure the accuracy of information, Prime Creative Media will not accept responsibility for errors or omissions or for any consequences arising from reliance on information published. The opinions expressed in Waste Management Review are not necessarily the opinions of, or endorsed by the publisher unless otherwise stated.
6 / WMR / August 2023
DELIVERING A GREENER FUTURE
Komptech CEA is a leading supplier of machinery and systems for the treatment of solid waste through mechanical and mechanical biological treatments, as well as the treatment of biomass as a renewable energy source. Komptech CEA is proud to provide innovative solutions for handling waste and biomass.

Komptech CEA’s extensive range of products cover all key processing steps in modern waste handling. At Komptech CEA the focus is always on innovative technology and solutions ensuring maximum benefit to the customer. Like to know more? why not speak to one of our team today?
SHREDDERS TROMMEL SCREENS STAR SCREENS WINDROW TURNERS



1300 788 757

TERMINATOR
Where Function Meets Technology
A slow-running, single-shaft shredder suited to all types of waste.


CRAMBO
Less Fuel, More Power
Ideal for shredding all types of wood and green cuttings.
TOPTURN X
The Ideal Combination of Performance and Design
With a sturdy frame, powerful hydraulics and large drum, the Topturn X is ready to handle any work situation.
MULTI STAR
Screening with a Star
Makes waste wood and biomass processing highly efficient.
NEMUS
Robust and Reliable
Combining the practice-proven virtues of its predecessors with new solutions for even greater performance.
AXTOR

Shredding and Chipping Made Easy
One of the most versatile machines around for processing wood and green cuttings.
komptechcea.com.au
$8M for waste-to-energy projects
The Victorian Government has funded 24 projects to create renewable energy from organic waste that would otherwise end up in landfill.
More than $8 million has been provided through the Waste-toEnergy – Bioenergy Fund which is supporting farming and food production, and other industry sectors to turn organic waste –including agricultural, livestock, food, and wood waste – into electricity, heat, gas, or liquid fuel.
The funding supports a range of Victorian businesses to transition their operations to renewable energy and drive down their emissions.
The projects are forecast to boost Victoria’s renewable energy capacity by an additional 6.82 megawatts (MW), enough to power 3410 homes with renewable energy.
Ingrid Stitt, Environment Minister, said the funding sends a strong signal to the state’s industries of the critical role waste-to-energy has towards reducing emissions.
“These funded projects will create regional jobs and income streams for farmers, while increasing Victoria’s bioenergy generating capacity by over 6.8 megawatts,” Stitt said.
“This is a win for cutting the amount of waste we send to landfill, a win for generating more renewable energy in Victoria, and a win in helping drive down our emissions.”
Goulburn Valley tomato grower Katunga Fresh has received a $1 million grant to turn spent tomato plants into a gas that will be used to heat the grower’s glasshouses, with excess gas returned to the grid.
Another project will allow dairy business Australian Consolidated Milk to convert cheese whey waste into biogas that will be used to power its dairy manufacturing plant, reducing reliance on fossil fuels.

Gayle Tierney, Minister for Agriculture, said the projects will allow producers to become more energy efficient while providing them with new opportunities to develop new revenue streams. Funded projects will create up to 192 shortterm jobs.
Minister rules on Wanless Park
The Queensland Government has refused part of the Ministerial Call In for the development application for the Wanless Recycling Park in Ipswich.
Steven Miles, Deputy Premier and Minister for Planning, has approved the resource recovery facility and waste transfer station and refused the landfill and void rehabilitation components of the development application, following advice from the Department of State Development, Infrastructure, Local Government and Planning.
Miles said the proposed resource recovery facility and waste transfer station facility supports the government’s vision for a zerowaste society, supports jobs, and contributes to the local economy. However, key reasons cited by the department for refusal of the landfill and void rehabilitation components include no demonstrated requirement for additional landfill capacity, insufficient economic benefit, non-compliance with applicable planning instruments and significant community concern and opposition.
Waste company Wanless had proposed to construct a resource recovery and recycling precinct at Ebenezer, southwest of Ipswich CBD.
In September 2021, the Ipswich City Council rejected part of the application for a new landfill while supporting the transfer and resource recovery facility.
In January 2022, the Queensland government called in the application to allow an assessment of the project, including its ability to support the waste reduction and recycling objectives.
8 / WMR / August 2023 News
Australian Consolidated Milk will convert cheese whey waste into biogas.
WASTE MANAGEMENT SERVICES




Specialising
Family owned and operated.
in Prescribed Hazardous Waste/EPA Regulated Waste with a fleet of licensed vehicles, including tankers and rigid trucks collecting waste from Automotive, Manufacturing, Industrial and Construction Industries.
nationalresourcerecovery.com.au
For additional information or a confidential consultation on any of our services, please contact us 03 9720 4177
| P.O. Box 267, Bayswater 3153
Follow the crumbs in Tasmania
The Tasmanian Government expanded the use of crumb rubber in the state’s road resurfacing tenders from 1 July 2023.
Michael Ferguson, Minister for Infrastructure and Transport, said the opening of a new crumbed rubber blending plant in Launceston demonstrates the growing use of recycled materials in road surfaces, underpinning a record road and bridge infrastructure program in Tasmania.
He congratulated Fulton Hogan for its commitment to promoting sustainability in its roadworks operations, with its new Mowbray plant now employing 50 Tasmanians.
A total of 18 sites were completed using a crumb rubber asphalt mix during the state’s 2022-23
resurfacing season. Following the civil construction industry’s positive response to the initiative, crumbed rubber has been expanded into the government’s broader resurfacing tenders from 1 July 2023.

“Through the Department of State Growth, we are expanding the use of crumb rubber in the state road resurfacing program,” Ferguson said.
“Nine sites will be targeted for resurfacing using crumb rubber in 2023-24, with consideration also given to including crumb rubber in some new construction projects.
“We are providing $4 million over four years to assist industry through the transition to using crumb rubber in road resurfacing and ensure there is no disruption to our roads program.”
He said the government will continue to work with industry to look for further opportunities to expand the use of crumb rubber in road resurfacing in the future.
In November 2022, the government began an expression of interest process for its Waste Tyre Reprocessing Grant Program: Roads to Resource Recovery.
Under the program, the government will provide up to $3 million to partner with industry to develop a rubber crumbing plant, or provide alternative and sustainable solutions for the recovery of end-of-life tyres.
The primary focus of the grant program is to invest in a rubber crumbing plant to produce materials for reuse in road surfacing across Tasmania.

10 / WMR / August 2023 News
Eighteen sites were completed using a crumb rubber asphalt mix during the Tasmanian 2022-23 resurfacing season.
Pure unites people and technology to transform the circular economy through advanced resource recovery.

We strive to be Australia’s leading resource recovery specialist, providing viable solutions to meet our customers needs.



pure-environmental-pty-ltd 10/333 Queensport Rd North, Murarrie QLD 4172 T: 1300 652 774 E: info@purenv.au W: purenv.com.au pure transforming the circular economy
Hungry fungi
UNIVERSITY OF SYDNEY RESEARCHERS
Polypropylene is a common plastic used for a variety of products from packaging and toys to furnishing and fashion. According to the University of Sydney, it accounts for about 28 per cent of the world’s plastic waste, but only one per cent of it is recycled.
A team of University of Sydney researchers have found strains of fungi that will degrade plastic over time. The team hopes to use its findings to develop disruptive recycling technologies, especially those driven by biological processes, that improve the circularity of plastics.

Amira Farzana Samat, a PhD student under the supervision of Professor Ali Abbas, a Professor of Chemical Engineering at the University of Sydney and Australia’s Chief Circular Engineer, and Dee Carter, Amira’s Co-supervisor and Professor in the School of Life and Environmental Sciences at The University of Sydney, were all involved in the research into the plastic’s degradation.
“A biological approach has attracted increasing interest over the past decade as a form of low-energy waste recycling,” Amira says. “Fungi possess mycelium, a root-like structure with the ability to bind to most surfaces, and can produce enzymes to degrade polymers or utilise carbon in the polymer chain as their carbon source.”
The trio have been conducting research into two types of fungi, Aspergillus terreus and Engyodontium album, and their ability to break down polypropylene after being pre-treated
with either UV light or heat.
Ali says the fungi reduced the plastic by 21 per cent over 30 days of incubation, and by 25-27 per cent over 90 days.
“A. terreus is a fungus commonly found in soil and is predominant in tropical and subtropical climates. They can also be isolated from decaying vegetation, specifically in compost heaps and hay silage,” he says.
“This fungus was known to produce acids, cholesterol-lowering drugs, and many biologically relevant compounds such as enzymes, for biotechnology purposes. Making it a great specimen for this research.”
Ali says that unlike A. terrus, Engyodontium genera (E. album) is rarely used in biodegradation studies.
“Only one paper mentioned the utilisation of E. album on the degradation of PP,” she says. “It showed a promising result, that lead to the current exploitation of this fungi.

“This fungus is usually found on plant materials, soil and marine sediments.
It can produce the laccase enzyme, one of the key enzymes responsible for plastic degradation.”
Professor Dee Carter, an expert in mycology (the study of fungi) and co-author of the study, says that fungi is versatile and known to be able to break down many substrates, offering a solution to plastic pollution.
“This superpower is due to their production of powerful enzymes, which are excreted and used to break down substrates into simpler molecules that the fungal cells can then absorb,” she says.
“Often, these fungi have evolved to break down woody materials, but this ability can be repurposed to attack other substrates.
“Recent studies suggest some fungi may even degrade some of the ‘forever chemicals’ like PFAS (Per- and polyfluoroalkyl substances), but the process is slow and not yet well understood.”
There is a hope, through this research, that the biological method could one day reduce the amount of plastic polluting
HAVE FOUND TWO STRAINS OF FUNGI THAT COULD OFFER A SOLUTION TO HELP BREAK DOWN POLYPROPYLENE NATURALLY UNDER CERTAIN CONDITIONS.
FEATURE NEWS 12 / WMR / August 2023
Aspergillus terreus on the Potato Dextrose agar (a growing medium for the fungi).
Engyodontium album on the Potato Dextrose agar.
the environment. Amira says she hopes the research leads to a greater understanding of how plastic pollution might biodegrade naturally under certain conditions.
“The vast majority of polypropylene isn’t adequately recycled, which means it often ends up in our oceans, rivers and in landfill,” she says.
“It’s been estimated that 109 million tonnes of plastic pollution have accumulated in the world’s rivers and 30 million tonnes now sit in the world’s oceans – with sources estimating this will soon surpass the total mass of fish.
“Since completing this part of the research, we have isolated other micro organisms from the marine environment and used a similar process to degrade marine plastic waste, with preliminary results showing better degradation.”
Amira says that this research is just the beginning and the team hopes to receive funding to continue digger deeper.
She says the study has not optimised the experimental conditions and there is room to further reduce the degradation time. Something the team hopes to look further into with ongoing support.
For more information, visit: www.sydney.edu.au
TRANSFORM WASTE INTO USEABLE MATERIAL

ALLU Material Processing Buckets turn waste into profit by producing aggregates and reusable materials from bricks, concrete, metals, wood, cardboard, glass, asphalt, waste soil or just about anything.


Wet or dry.
One ALLU can produce multiple fragment sizes, with various blade and drum configurations.
For excavators and loaders from 8t to 160t.
Processing times, cycle times and processed tonnes can be viewed and analysed via ALLU app
Scan for ALLU dealer locations in Australia or visit attachmentspecialists.com.au/allu


“Recent studies suggest some fungi may even degrade some of the ‘forever chemicals’ like PFAS.”
Professor Dee Carter University of Sydney
Ali Abbas and Amira Samat hope to expand their research.
Hazardous & Regulated Waste
WestRex Hazardous & Regulated Waste
Our sustainable range of hazardous waste treatment technologies and regulated waste disposal services are focused on maximising resource recovery from various waste streams and reducing the volumes of waste going into landfills.

WestRex are licensed to receive the following types of hazardous and regulated wastes: & Sludges Mud & Fluids

Tour of duty
AS TONY KHOURY STEPS DOWN FROM HIS ROLE AS EXECUTIVE DIRECTOR OF THE WASTE CONTRACTORS AND RECYCLERS ASSOCIATION OF NEW SOUTH WALES, HE REFLECTS ON MORE THAN 30 YEARS IN THE INDUSTRY.

Australia’s waste and recycling industry has a way of enmeshing those who work in it. Once you’re in the industry, generally you are here to stay.
Tony Khoury is testament to that. When the Fellow Certified Practicing Accountant took up the role of Financial Controller for Pacific Waste Management in New South Wales in 1991, it began a more than threedecade long commitment to the industry.
He moved on to Clinical Waste Australia where he was tasked with raising the required capital to upgrade the emissions system so that air quality met the then new Environment Protection Agency environment standards.
Today, the plant operated by Cleanaway Daniels Silverwater Medical Waste Services, is still in operation and is the last of the medial waste incinerators in NSW.

“It wasn’t as complicated or challenging back then,” Tony says.
“The waste and recycling sector is a much more sophisticated and complex industry in 2023 than it was in the early 90s.
“Thirty years ago, you’d provide a driver with a run sheet, he’d pick up the waste and drop it off. Today there are more laws, regulations, policies, procedures, and restrictions.”
The now Executive Director of the Waste Contractors and Recyclers Association (WCRA) of New South Wales, Tony has helped shape the association and turn it into a successful business entity, supported by its members and sponsors, and respected by stakeholders, including across all levels of government.
WCRA members own, operate, or control an estimated 90 per cent of the available commercial waste and recycling collection vehicles used in New South Wales and the Australian Capital Territory.
Tony’s acutely aware of the many and varied challenges faced by business operators – he references demands for better customer service, cost control, higher productivity, workplace health and safety issues, skills and labour shortages, the challenges posed by the introduction of new laws and regulations, insurance issues, and the urban sprawl, to name a few.
A staunch advocate of the industry, he’s shared his knowledge, providing training opportunities for workers including delivery of nationally accredited TAFE material across the waste management sector.
There’s been many successes along the journey.
Tony describes as “wonderful”, watching the evolution of occupational health and safety laws and national heavy vehicle regulations into national systems, laws and regulations, and his involvement in the introduction of the federal Waste Management Award 2010 (now 2020) that governs payment and conditions to all waste and recycling workers.
“It was a big job,” he says. “In developing the Award, WCRA was the only waste employer body consistently involved in the Fair Work Commission (FWC’).
“Now that it is in place, this Award has removed aggressive behaviour from the wage negotiation process with the FWC handing down an annual increase on 1
July of each year. We also have the Fair Work Ombudsman providing advice when workers and employers require support.”
Tony says one of the biggest challenges has been a lack of waste and recycling infrastructure across NSW and a disconnect between government expectations and business.
He says Sydney needs more disposal solutions in the metropolitan area. The current network of transfer stations funnels putrescible waste to the Woodlawn Eco Precinct near Goulburn and Lucas Heights for disposal.
“If there’s a breakdown in the system, or an oversupply as happens during wet weather or from bushfires, the whole system goes into stress,” Tony says.

“We require disposal solutions within the Sydney metropolitan area. Transfer stations are great, but that’s all they are, transfer facilities, not end-disposal points.”
He says a combination of factors have added to the challenges – population
INDUSTRY INSIGHT www.wastemanagementreview.com.au / WMR / 15
Tony Khoury has helped shape some pivatol national systems for Australia’s waste sector.
growth, a “throw-away society” where everything has an expiration date, an abundance of packaging materials and the closure of waste facilities over the years.
The answer, Tony says, is energy-fromwaste (EfW), but state regulations have forced the withdrawal of several projects.
“Unless things change, it is highly likely that within a decade, Sydney will experience a significant waste disposal problem. I don’t know of any other way of disposing of waste residues other than landfill or energy-from-waste.
“We can minimise the amount of waste we generate, and we can recycle more (via bins with yellow and green lids), but when it comes to the contents of the bin with the red lid, I don’t know how else we can get rid of this waste residue.”
The only live application for EfW in New South Wales is one by Veolia for a facility at Woodlawn. Tony believes it’s important for this application to be approved, not only for the waste industry, but to provide a reference point for regulators of what is possible and what good quality EfW infrastructure should look like in the state.
But even if Woodlawn is approved, there will still be an element of time involved to construct the facility.
“For the business sector to invest there needs to be certainty that regulations will not change, along with an opportunity for
an adequate rate of return on investment,” Tony says. “Many waste and recycling projects take 15 to 20 years for capital to be depreciated and for the organisation to obtain a payback on the investment.
“With the right regulatory settings, industry will develop the confidence to raise the required capital to invest in further processing solutions for New South Wales.”
The state’s waste levy is another area that needs addressing. Tony says increases in the levy have led to waste being transported from New South Wales to Queensland.
“At the height of the issue, 1.8 million tonnes of waste a year was leaving New South Wales to go to South-East Queensland for no reason other than to avoid payment of the levy,” he says.
“The waste levy was designed to encourage resource recovery and diversion from landfill and should not be used by transporters to subsidise the cost of longdistance transport. While it can be argued that it is an economic decision to avoid paying the levy, in reality there are very significant road safety and environmental issues involved.”

In Tony’s 33 years in the industry, the New South Wales waste levy has increased from $2 per tonne in 1991 to the current level of $163.20.
In terms of unfinished business, Tony believes there should be strong
consideration given to harmonise waste management laws into a federal system.
“Having six states and two territories with their own waste management laws is a bit archaic,” he says, while adding that “550 councils across the country making different decisions on waste and recycling is also far from ideal”.
Tony plans to finish up with the Waste Contractors and Recyclers Association NSW late in 2023 and is hoping to pursue a board opportunity.
In January 2017, he completed a formal program and passed the required exams admitting him to the Australian Institute of Company Directors. He has held a number of board positions including Sydney Catholic Cemeteries where he chaired the Audit & Risk Committee and currently with DOOLEYS Lidcombe Catholic Club where he chairs the Sports Council.
As well as being an FCPA, Tony is a Fellow Member of the Institute of Corporate Governance, a Fellow Member of the Australian Institute of Company Directors, holds a Bachelor of Business Degree, a Diploma in Corporate Management and has a Certificate IV in Training & Assessment TAE40110.
He describes his time with WCRA as the best years in his working career.
“In my travels around the world, nobody does containerisation, transport and collection of waste better than the Australian waste and recycling industry,” he says.

“All aspects of the system are consistent, workers are very well trained, the equipment used is at a very high standard, productivity is generally high and work health and safety standards are the highest I’ve seen.
“As transporters we are number one in my opinion, and we should all be very proud of that.”
To view the activities of WCRA, visit: www.wcra.com.au
16 / WMR / August 2023 INDUSTRY INSIGHT
Tony Khoury describes his time with WCRA as the best years in his working career.





1800 465 465 wastech.com.au BUILDING SMARTER EQUIPMENT TO HELP MINIMISE THE WORLD’S WASTE Wastech Engineering is the distributor of McCloskey Environmental in Australia. TROMMELS STACKERS SHREDDERS SCREENERS
The Breakdown
‘The Breakdown’ is a monthly column giving industry leaders and decision makers a chance to share their views on topics central to the sector.





This month we asked: ‘How can legislation better support waste-to-energy in Australia?’
Clear, nationally aligned guidelines should be developed to promote waste-to-energy adoption, covering waste segregation, disposal regulations, and emission standards. Financial incentives and grants can encourage investments, making it economically viable. Streamlining the permitting process and maintaining environmental assessments ensures efficient project development. Monitoring and reporting mechanisms should be stringent to ensure compliance and transparency, fostering an environmentally conscious waste-to-energy sector. Research and development programs must be strengthened, encouraging innovation through collaboration. Public awareness campaigns can address misconceptions, educate the community, and garner support for waste management efforts.
WCRA commissioned the Centre for Economics to undertake a review of waste-to-energy regulations and to determine the economic and environmental impacts of New South Wales regulations. Current regulations have resulted in about $2b of capital expenditure not proceeding on waste-to-energy in NSW. The last remaining proposal is the Veolia proposal for WtE into Woodlawn. WRCA absolutely supports that proposal. That facility, if it gets up, will give NSW regulators a reference point for what good, quality wasteto-energy should look like. The last thing NSW needs is another failed WtE proposal.
As we don’t recover the energy content of combustible waste consistently across Australia, it perpetuates our reliance on landfill. There are more than 500 WtE facilities operating in Europe without causing material impacts to human health or the environment. While WA and Victoria have made progress in enacting legislation to enable WtE, other jurisdictions have more constrained frameworks. To ensure WtE plays a more effective role in the waste hierarchy in Australia, we would benefit from greater flexibility to support industrial facilities pivoting to alternate fuels, a national harmonisation of regulatory frameworks, removing ambiguity around licensing and approval risk, and streamlining approvals in dedicated waste infrastructure precincts to reduce sovereign investment risk.
Better legislation should support the circular economy and not only waste-to-energy (WtE). Enforceable source separation legislation would stop the leakage of organics and recyclables into landfill. The choice between a landfill and WtE is mainly economic, which brings me to the low and inconsistent landfill levies. The levy should go uniformly to $250/t to account for the high local cost compared with the current $200/t in the United Kingdom. Invest the levy into infrastructure, not a general tax. Such legislative and financial signals will drive change, avoid emotional caps on WtE, and bring certainty to the community, industry, and investors.
If you or someone at your organisation is an industry leader and would like to be a part of this monthly column in 2023, please get in touch with Editor, Lisa Korycki lisa.korycki@primecreative.com.au
Tony Khoury Executive Director, Waste Contractors & Recyclers Association of NSW (WCRA)
Brad Searle Acting Chief Growth Officer, BINGO
Brett Lemin Executive Officer Victorian Waste Management Association
Dr Marc Stammbach Managing Director, Hitachi Zosen Inova Australia
OPINION 18 / WMR / August 2023
Versatility that’s good for business
Versatility is what distinguishes the DAF range from other trucks in its class. So you’re in the business of transporting liquid goods? There’s a DAF for that!

Whether your needs are long-distance haulage, city distribution, construction transportation, bulk or tank transport, the versatility of DAF keeps you moving, and that’s good for business.

A PACCAR COMPANY DRIVEN BY QUALITY SEE DAF VERSATILITY IN ACTION DAF PURE EXCELLENCE
Thirty and beyond
AUSTRALIAN MANUFACTURING COMPANY WASTECH MARKS A MAJOR MILESTONE AND SETS A VISION STATEMENT FOR THE FUTURE.

What does Wastech beyond 30 look like?
For Clete Elms, it’s acknowledging the work of founding brothers Neil and Paul Bone, while pivoting the company to the future to ensure it’s around for another 30 years.
The recently appointed Chief Executive Officer has a clear vision of growth to transform the engineering, manufacturing and service company into a truly national end-to-end and resource recovery solution provider.
“The industry has changed,” Clete says. “Companies are taking more
ownership of their waste management and realise resources are precious.
“Wastech sees a real opportunity to become sustainability experts through technology and industry innovation.
“We want to supply global-leading equipment to help take resource recovery into the future.”
SOLID FOUNDATIONS
Wastech was founded in 1993, designing and engineering solutions for the waste management and resource recovery sector. It’s grown to more than 100 employees across Australia and has
partnered with global brands to offer a stable of cutting-edge equipment contributing to the nation’s path to a circular economy.
Known for its technology-enabled solutions, Wastech is driven by the goal of environmental sustainability. It does not just question the “what if” but explores “how will it be done” and “how to make it happen”.
Clete’s appointment is a strategic move to build on recent years’ momentum and leverage the Bone brothers’ expertise. Clete is an executive with 20 years of experience with ASX-listed
COVER STORY 20 / WMR / August 2023
corporations, including Cleanaway and Boral. He’s drawing on his results oriented operational background to drive a high-performing, customer-centric culture at Wastech. That, he says, means being responsive to customers and the market.

Clete is aiming to identify emerging market segments and build a leadership team and a business that responds to them.
PEOPLE POWER
“We’re looking to be the solutions provider of choice for the resource recovery sector with a range of products that meet a range of requirements,” Clete says. “That has a lot to do with increasing our bench strength at Wastech
and getting people with the right skill sets into the business. For sales and marketing, that means professional sales executives who understand customer value proposition as well as the industry.
“For production, it means highly efficient design and manufacturing capabilities combined with a highly engaged workforce.
“For service, it means empowering our technicians with leading edge workforce planning systems to make their ability to meet customer requirements seamless.”
Proudly Australian, Wastech is a recognised leader in consulting, designing, and manufacturing waste handling equipment. From cardboard, plastic and polystyrene to e-waste and general waste, it’s developed a range of products and services to meet all waste types.
Head office and manufacturing remain in Victoria. Service and repair centres in Brisbane, Sydney, and Perth all stock a large range of spare parts, while skilled technicians operate 24/7 Australiawide and can attend on-site to service, repair and refurbish all products in the industry.
The aim, Clete says, is for Wastech to be a one-stop shop for the waste and resource recovery sector. But it’s customer service that will set it apart.
“We’re aiming to be an industry leader in design, development, manufacture as well as repairs, parts, and service,” he says. “We’re creating processes and structures to enhance our core business that will only help us continue to grow.”
GLOBAL PARTNERS
The key to growing the business is global partnerships. Wastech is the Australian and New Zealand distributor of Fire Rover, an early fire protection solution that can detect and extinguish fires before they start.

It has exclusive rights to Bramidan Balers and Flexus Balasystems. In December 2022, Wastech signed a deal to distribute McCloskey Environmental equipment when the 35-year mainstay in crusher, trommel and screen design branched out into the waste and recycling sector. Wastech is also bringing robotic sorting technology into the fold, as well as odour control and alternate day covers for landfills.
“There are companies who might provide one or two services or products, but from a waste equipment point of view, no one offers everything and to the extent that we do,” Clete says.
“The breadth of services we offer can assist just about any customer with their resource recovery requirements.”
www.wastemanagementreview.com.au / WMR / 21
The future looks bright for Australian engineering and manufacturing firm Wastech.
Clete Elms, Chief Executive Officer, has a clear vision for Wastech’s future.
Bringing the shiniest and newest technology on shore is not all a rush. Clete says partnerships must be the right fit for both parties, and there should be a need for the technology in Australia. It comes back to the company ethos to be responsive to the market.

Brand reputation, product quality and an appetite for growth are also important.

“We live and die by the products we introduce,” Clete says. “We do have a great reputation for supplying products that last and do more than what we say they will do.
“We’re always looking to innovate and bring new technology. But it’s about ensuring the options we’re putting forward are sustainable and providing a closed loop where possible.”
22 / WMR / August 2023 COVER STORY
Manufacturing is based in Victoria but there are plans for additional locations in Sydney and Brisbane.
CIRCULAR SOLUTIONS
Closed-loop solutions are gaining more importance as Australia pushes toward a circular economy and national waste targets, including an 80 per cent average recovery rate from all waste streams by 2030.
Despite aiming to reduce the total waste generated in Australia by 10 per cent by 2030, waste generated increased by three per cent compared to 2018-19, according to the 2022 National Waste Report. That’s expected to continue to grow in line with population growth.
Clete says an increase in the amount of waste generated is also combined with an increase in client expectations for new ways to collect, transport, treat, process and recycle it. He uses the example of an evolving tonne to put the changing

waste landscape into perspective. Thirty years ago, a tonne of household rubbish would have gone directly to landfill. Now part of that tonne is sent to a materials recovery facility, part to organics recycling, possibly part to a glass beneficiation plant, with the remaining reduced residual component to landfill.
Escalating landfill levies also means it’s now more economically viable for companies to invest in the capital required for waste processing equipment.
“For a tech provider like us, there’s a whole lot of other things we can do for waste generators to meet their circular economy aspirations,” Clete says.
Looking ahead, Clete’s 10-year vision is for Wastech to be a partner of choice across a broad client base, whether it be a waste management company, retailer,
or waste generator. Expansion across the eastern seaboard, organically or partnering with like-minded businesses, is also on the cards.
He’d like to see fabrication decentralised from Victoria with additional locations in Sydney and Brisbane.
It’s a big ask, but Clete is looking forward to it.
“I like to build businesses and successful teams,” he says.
“This is an industry I’m passionate about and know well. Wastech presents a terrific opportunity to build up a business that responds to that industry We have the appetite for growth and expansion.”
For more information, visit; www.wastech.com.au
www.wastemanagementreview.com.au / WMR / 23
Wastech has been designing and manufacturing waste management solutions since 1993.
LEEF it to Water & Carbon Group
AN AUSTRALIAN DEVELOPED FOAM FRACTIONATION SYSTEM FOR PFAS REMOVAL IS GAINING GLOBAL RECOGNITION IN LEACHATE TREATMENT.
Aban on PFAS use is the only way to eliminate per– and polyfluoroalkyl substances (PFAS) contamination.
But you’d have to strip back the manufacturing process of many everyday products, from baking paper, non-stick cookware to cosmetics, carpets, and clothing, that it’s too big of an ask, says Mark Mullett, PFAS and Mining Development Manager for the Water & Carbon Group (WCG).
He says there are no official discussions around trying to reduce the
amount of PFAS that consumers use, but it’s a hot topic among waste and recycling operators who are left with the financial impost of cleaning up the forever chemical.
Landfill operators are often challenged by treating and managing PFAS in leachate and groundwater. One of the main difficulties is the complex chemistry of the leachate –high salinity, organic carbon, nonbiologically degradable compounds, suspended solids, and nitrogen compounds, particularly ammonia, are present.
“There are a lot of PFAS removal technologies available that all have their sweet spots in terms of the feedwater source chemistry,” Mark says, “but it’s very hard to find a solution to treat all of them.
“No single process can be developed for just any leachate. Even within a single landfill site, the leachate sources are sufficiently different to require their own assessment and process development.”
Granular activated carbon (GAC) absorption and ion exchange resins have been used to treat PFAS in simple waste streams.
Mark says membrane processes such as reverse osmosis (RO) can be applied to leachate treatment, but the volume of concentrated waste produced is high, 20-50 per cent of the raw leachate volume, resulting in high waste disposal and energy costs.
This is even more apparent when the RO concentrate is further treated using high energy evaporation processes to drive the excess water off as steam.
WCG has developed the LEEF (Low Energy Evaporative Fractionation) System to remove PFAS contaminants by harnessing air, and the chemical properties of PFAS itself, while using minimal energy, and no consumables.
PFAS are surfactants that can produce a stable foam when mixed with air and water. This characteristic is the reason PFAS is effective as a firefighting foam to suppress certain types of fire.
The LEEF System takes advantage of the way PFAS coats air bubbles in a process called foam fractionation. By adding air in a controlled setting, PFAS compounds will attach to bubbles and rise to the top where they can be skimmed off and separated.
Mark says the LEEF System has worked on some of the most challenging chemistries he’s seen in leachate.
“The LEEF System is not impacted by the co-contaminants and is quite robust to suspended solids,” he says. “It’s why foam fractionation in general is being considered the primary treatment option for leachate.”
The LEEF System is in full operation at the Shoal Bay Leachate Treatment Plant in Darwin, where it is successfully treating 50 million litres of leachate each year as part of a

FEATURED TOPIC – HAZARDOUS AND LIQUID WASTE 24 / WMR / August 2023
The LEEF system has been proven to successfully treat leachate.
holistic zero liquid discharge leachate treatment regime.
It’s also had success in treating about a dozen of the toughest leachates in US states including Tennessee, Vermont, Alabama, North Carolina, and Virginia in demonstration and pilot scale trials. The demonstration plant uses fullsized commercial fractionators to treat more than 12,000 litres per day in continued operation.
Mark says the level of demonstration has given clients confidence in the LEEF process and many are taking a proactive approach to implement solutions that best suit their situation.
That’s been spurred on by a US Environmental Protection Agency proposal for nationally enforceable limits for six PFAS compounds that are commonly found in drinking water. The regulation will require various industries, including landfill operators and those involved in leachate
management, to proactively prepare for compliance in advance.
WCG is also receiving requests for treating water from mining run-off, groundwater influenced by hydrocarbons, and landfill sources that carry industrial waste, not putrescible household waste.
“These are quite problematic in their own way for traditional treatment that are compromised by the background chemistry,” Mark says. “In some cases, very complex pre-treatment is required to accommodate the traditional removal technologies to eradicate contaminants.
“Each of these pre-treatment stages can produce its own PFAS contaminated waste. In these instances, the LEEF System has many advantages including operational efficiency and being cost-effective, and sustainable.”

The Water & Carbon Group continues to invest in a development
program at bench and pilot scale to refine and improve operations, and to develop operating parameters for more feed source types.
Mark says Australia’s proactive approach to PFAS – the government recognised PFAS as a potential problem far earlier than some other countries and has developed a nationally agreed guidance on the management of PFAS contamination in the environment – has resulted in many innovations, such as the LEEF process, originating in Australia.
“Australia has always been on the ball with PFAS and is a pioneer in terms of solutions development,” he says.
“To see these being exported, along with enhanced technical knowledge in terms of understanding PFAS and PFAS abatement, is very exciting.”
For more information, visit: www.waterandcarbon.com.au
www.wastemanagementreview.com.au / WMR / 25
The LEEF System has worked on some of the most challenging chemistries found in leachate.
Charging ahead
E-WASTE RECYCLER ECOCYCLE IS AHEAD OF THE GAME WHEN IT COMES TO CREATING A CIRCULAR ECONOMY FOR ELECTRIC VEHICLE BATTERIES.
The Electric Vehicle (EV) revolution is advancing.
Sales of electric vehicles in Australia more than tripled during the first four months of 2023 compared to the same period last year, according to CarExpert.
That number is expected to continue to rise as consumers seek out lower emissions, improved health outcomes and reduced running costs. Growing the national EV market is also at the heart of Australia’s first National Electric Vehicle Strategy, launched in 2023.
But the increased uptake has a downside. Research commissioned by the Battery Stewardship Council, released in June 2023, estimates used EV batteries entering the waste stream will reach 30,000
tonnes by 2030 and 1.6 million tonnes by 2050.
Currently, EcoBatt, the battery recycling division of e-waste recycler Ecocycle, is the only safe and efficient national solution for used EV batteries.

The Battery Stewardship Council is urging government and industry to begin discussions now to be prepared for the emerging waste stream.
Ecocycle is getting ahead of the game, investing in equipment and technology to collect and recycle used EV batteries.
Zoltan Sekula, Product Stewardship Manager for Ecocycle, says it’s too late to shut the gate once the horse has bolted.
“It’s coming, and somebody needs to be at the front,” Zoltan says. “Ecocycle has made it a mission to be ready, have
the right equipment and have everything in place.”
Lithium-ion batteries have come under scrutiny globally for their propensity to catch fire under certain adverse handling conditions. Their high voltage brings difficulties at end-of-life, requiring extra safety, specialised tools, protection, and training.
Zoltan says Australia does not have an official training program or code of practice when it comes to handling EV batteries. He says change is needed right through the supply chain.
The main issue is the high voltage of batteries – up to 800 volts. Even when classed as end-of-life, EV batteries can have a usable residual capacity. Not everyone can, or should, work with these
FEATURED TOPIC – HAZARDOUS AND LIQUID WASTE 26 / WMR / August 2023
Ecocycle has invested in specialised containers large enough to safely transport EV cars involved in an accident.
batteries particularly from a safety aspect, Zoltan says. “Anyone who believes it’s just a battery is wrong. It can cause severe injury, death and fire if not handled correctly,” he says. “Safety is paramount. They are dangerous goods and need to be respected accordingly.”
Ecocycle has undertaken its own staff training, following safety guidelines from the EV battery recycling industry in Germany and is working closely with the Institute of Scrap Recycling Industries (ISRI).

Zoltan says there needs to be a qualification program in Australia for people to work with high voltage EV batteries.
“Even at 10 per cent charge, an EV battery is a high-risk item,” he says. “There’s still enough energy there to start a fire or injure someone.”
Ecocycle has purchased special safety containers for transportation of EV batteries. The containers are equipped with built-in monitoring and fire retardant. In the case of a thermal runaway, the fire will be self-contained.
The company has also installed a Fire Rover, an early fire protection solution that can detect and extinguish early fires at every yard where EV batteries will be stored or recycled.
EV batteries in cars that have been involved in an accident have the potential
to reignite two to three weeks later, which is why Ecocycle has invested in containers large enough to safely transport cars.
“EVs involved in an accident can catch fire in transit on a tow truck,” Zoltan says.
“With these self-contained safety containers, it’s not going to be a problem. Monitoring will detect any heat build-up.”
A member of the Association for the Battery Recycling Industry, Ecocycle has a national reach with household battery collection points in major supermarkets across Australia, including regional and remote areas. Zoltan hopes that under a stewardship program for EV batteries the company can roll out the safety containers Australia-wide.
“Ecocycle will facilitate the vehicle to be transported safely, either to an insurance company or back to us. Ideally, we would then be responsible for dismantling the vehicle and removing the batteries for recycling.”
Repurposing of EV batteries is a hot topic. Batteries replaced in cars still have enough capacity to be used for energy storage devices such as solar power or broken down into back-up batteries for the leisure market, including caravans.
The elements used to create EV batteries, including cobalt, nickel, and lithium, are also scarce so recovering them to be reused in the manufacture of new batteries will be important.

The EV battery recycling industry is expected to supply at least 10 per cent of resources to build new batteries. It’s one of the reasons it’s important that battery recovery and recycling is tightly controlled.
Ecocycle has the technology and expertise to repair, reuse and recycle the batteries to ensure they stay in circulation.
Zoltan says Ecocycle has made a commitment to ensure EV batteries are recycled to a world class standard with capacity to process the increasing tonnage to 2030 and beyond.
For more information, visit: www.ecocycle.com.au
www.wastemanagementreview.com.au / WMR / 27
Special safety containers for transportation of EV batteries have inbuilt monitoring and are fire retardant.
EV battery recycling requires specalised tools and training.






IT DOESN’T JUST MEASURE VALUES. IT HAS VALUES. THE 6X ®. AVAILABLE NOW! The VEGAPULS 6X: A radar level sensor that is not only technically perfect, it also takes the user into account. It’s easy to set up and at home in virtually any process or industrial environment. Made by a company that bases its decisions on values that are good for everybody. VEGA. HOME OF VALUES. www.vega.com/radar
A calculated risk
WESTREX HAS GROWN FROM A SINGLE FACILITY PROCESSING COAL SEAM GAS WASTE TO MULTIPLE SITES PROVIDING SUSTAINABLE SOLUTIONS TO A NICHE MARKET.
Hazardous waste generated in Australia continues to grow faster than other waste streams, and faster than the rate of population growth, according to the Department of Climate Change, Energy, the Environment and Water.
It can include everything from chemical residue to resin and industrial waste by-products which, if not handled correctly, have the potential to cause human and environmental harm.
Between 2010-11 and 2014, average annual growth of hazardous waste was nine per cent, with a 34 per cent increase between 2017-19, the department’s Hazardous Waste in Australia 2021 report states. The growth was attributed to asbestos and contaminated soils and large flows to storage of coal seam gas (CSG) waste.
It was this CSG waste that WestRex, now a subsidiary of Pure Environmental, foundation directors Mark Scott and Gregg Chapple had in their sights when
they began construction of a purposebuilt facility in Jackson, Queensland.
The original intention was to provide the CSG industry with a licensed waste processing facility, in the heart of the Surat Basin, capable of treating and processing effluent and other liquid and hazardous waste from the CSG camps.
The first load of effluent waste arrived at the site for processing in April 2013. Since then, WestRex has grown, with additional waste facilities in Wacol, Narangba and Injune.

FEATURED TOPIC – HAZARDOUS AND LIQUID WASTE www.wastemanagementreview.com.au / WMR / 29
An aerial view of the Wacol site.
David Powell, General Manager of WestRex, has been at the helm of the liquid and solid hazardous waste management company since 2013. David has an innate understanding of the dangers of hazardous waste, both to the people who handle them and the environment.
He describes every day in the industry as a “school day”, learning to deal with emerging wastes and an increasing appetite for sustainable solutions.
With a team of industrial senior chemists with more than 70 years
combined industry experience, including John Pesavento, Sachin Patel, Kali Martin and Kevin Yip, WestRex’s Wacol site is at the cutting edge of processing, treatment, and resource recovery of hazardous wastes.
The facilities are licensed to accept a range of regulated and hazardous wastes, with a focus on maximising recovery of reusable resources and minimising what’ sent to landfill.
THE WAY FORWARD
The Wacol site is licensed to receive bulk
liquid and industrial wash water that is processed through a water treatment plant, as well as packaged waste such as the drums or vessels that contain waste chemicals and flammable material.

David attributes the success of Wacol to WestRex’s reputation for providing the best service and value – which often isn’t all about price.
The company recruits chemists and has focused on providing sustainable disposal solutions for difficult to treat wastes. Because WestRex is independent, it caters to everyone in the waste sector.
30 / WMR / August 2023 FEATURED TOPIC – HAZARDOUS AND LIQUID WASTE
David Wrenn, Business Development Manager WestRex, has been servicing the industry for more than 25 years and is one of the leading experts in hazardous waste management.
“In the hazardous waste industry, you’re dealing with chemicals that have reacted or been blended with something else,” David says. “Each waste drum has different compounds that need to be considered when coming up with a disposal solution.
“We’re actively involved in managing our clients’ challenges in terms of
hazardous or toxic waste streams; that’s where our chemists and engineers work hard.
“For new and emerging waste streams we will work out ways to manage the compliant treatment, reuse, and or disposal of material.”
David says all the processes used are aimed at making a waste less dangerous, whether that’s through fixation –blending and binding a chemical with cement powder to form a solid waste for final fate disposal – or using specialised equipment, that has been designed to maximise the recovery and reuse of oil, sludge, and industrial wastewater.
Reuse is always a priority. Currently about one million litres per month of oil recovered at Wacol is sent for refinement and reuse in car engines – closing the loop on the waste stream.


The team works in close consultation with the waste hierarchy and always challenges itself to investigate and research opportunities to beneficially reuse certain regular hazardous waste streams. This could be through straight recovery or by processing to convert the waste into a reusable commodity.
“I see this as a growing opportunity to further divert hazardous wastes
that are fixated for landfill to be ‘remanufactured’ into products of use; by using a circular economy approach,” David says.
CPR, THE WESTREX WAY
He describes the WestRex team as dynamic and passionate about their values of compliant, professional, and responsive (CPR).
“Compliance is important to customers and generators. It’s something we hang our hat on,” David says. “We don’t do anything that’s not compliant. Dangerous goods need health and safety standards to ensure that no harm comes to staff, customers or surrounding environment.
“We’re professional in every interaction we have, and we’re responsive in terms of turnaround time from an initial inquiry to trucks arriving at the gate.
“We’re a solutions-focused business. We’re trying to innovate and stay focused on the customer. If they have something that’s hard to treat, we can treat it.”
For more information, visit: www.westrex.com.au or www.purenv.com.au
www.wastemanagementreview.com.au / WMR / 31
The WestRex Wacol site is licensed to receive bulk liquid and industrial wash water.
A team of industrial chemists ensures WestRex’s Wacol site is at the cutting edge of processing, treatment, and resource recovery of hazardous wastes.
Chemical Brothers, Chemical Beats
AS
A
NICHE
SEGMENT, CHEMICAL TRANSPORTATION BY ROAD OFTEN INVOLVES A DIFFERENT MINDSET TO FUEL HAULAGE. UNANDERRA TANKER HIRE IS ONE OF THE INDUSTRY’S LEADING PRACTITIONERS.

Unanderra Tanker Hire (UTH), a leading chemical transportation company based in Port Kembla, has recently acquired three DAF XF530 Euro VI prime movers. These additions have proven their worth in crucial areas such as fuel economy, driver acceptance, and safety.
As a specialist in chemical transportation, UTH caters to various industries with unique requirements. One of the new DAF XF530 trucks operates in Brisbane, delivering laundry chemicals and servicing breweries. The other two trucks are assigned to more traditional tanker tasks.
CHEMICAL NEEDS: GO
Unlike fuel or milk tankers, chemical transportation demands a focus not solely on optimising high-productivity combinations but also on meeting customer expectations and navigating challenging access points.
UTH addresses these challenges by using semi-trailers that offer the best compromise between productivity and accessibility. With a fleet of single trailers weighing 44 tonnes, UTH can handle tight entrances at metropolitan water treatment plants and waste station sites in regional areas.
Drivers at these sites are often confronted with problematic access that requires trucks to have cross-locks and power dividers, according to Jeremiah
Justice Wiedl, UTH General Manager. “Most of these entry points are just dirt roads better suited to a 4x4 passenger vehicle,” he says. “That’s where the big trucks don’t fit. We can make it work using a semi with a compartment of a product, and then we’ll leave. We reload the semi elsewhere and go away on a long trip.”
UTH’s chemical transportation operations are tailored to the needs of customers. UTH ensures that it delivers the precise amount of product required, whether it is 5000 or 20,000 litres. This meticulous approach to load optimisation
maximises fleet use and enables UTH to efficiently cater to a wide range of customer storage tank sizes.
UTH’s fleet comprises 21 rigids, primarily used for urban assignments. However, most vehicles are prime movers, totalling nearly 60 units. Alongside the three new DAF XF530 trucks, UTH operates five other DAF vehicles that have proven their reliability and versatility over the years. The decision to invest in DAF trucks was driven by their storage options, adaptability to urban confines, and performance.
FEATURED TOPIC – HAZARDOUS AND LIQUID WASTE 32 / WMR / August 2023
Storage options, adaptability to urban confines and performance are key selling points.
FLEXIBILITY IS KEY
UTH’s expertise extends to transporting hydrochloric acid, a critical component in the galvanising industry. With the flexibility afforded by the DAF trucks, UTH drivers can reload and embark on additional long-haul trips after completing early morning deliveries. For example, they may transport hydrochloric acid to gold mines in the state’s central west.
This flexibility enables UTH drivers to optimise their hours and cater to the diverse needs of their customers. It would be unheard of, Jeremiah says, in the fuel and milk markets.
Working under higher mass limits (HML), UTH has the provision for loading up to 46 tonnes of gross vehicle mass (GVM), although the payload rarely exceeds 25 tonnes.
UTH’s strategic decision-making has been pivotal in its growth and competitive positioning. The company’s approach to the total cost of ownership and technical proficiency has allowed for linear growth over the years. UTH has optimised its fleet and remains competitive by carefully considering traffic conditions, site access, and maintenance costs.
A mechanic by trade, Jeremiah emphasises the importance of maintaining and repurposing equipment. UTH’s fleet includes new and older models. The expertise of the company’s in-house workshop, supported by trusted external providers, ensures that the fleet remains well-maintained and reliable.
“I was brought up to try and maintain things and keep them going,” Jeremiah says. “That’s always been something Dad has emphasised from the start.”
The newest Euro VI DAF XF530 trucks are not, unlike some other European brands in the fleet, on contract maintenance schemes. Maintenance of the fleet in the main is performed in-house. The workshop employs six personnel, including a fabricator.
“The challenge with contract maintenance is you need to return to the dealer,” Jeremiah says. “If the fleet is not profitable, you’re paying a bloke to just sit with a truck at a dealership all the time. That becomes a false saving when you look at the wage component.”
FINDING THE GOLDEN PATH
The three new Euro VI DAF XF530 trucks have quickly become the preferred choice for UTH. Manufactured in the same factory where the company’s first truck was made, these DAF trucks offer readily available parts, competitive pricing, and improved cost of ownership. Jeremiah praises the XF530 turning circle, versatility, and support network.
“The chief reason is the impossible places we need to get into. You need a
conventional truck. Drivers need a truck with a really good turning circle. They’ve never let me down, and the drivers now love them,” says Jeremiah.
Unanderra Tanker Hire’s investment in the new DAF XF530 Euro VI prime movers marks a milestone in the company’s journey to revolutionise chemical transportation. By prioritising fuel economy, driver acceptance, and safety, UTH has set new standards in the industry.

With the performance of the DAF trucks and a dedicated team, UTH continues to thrive and adapt to the evolving needs of its customers.
For more information, visit: www.daf.com.au and www.uth.com.au
www.wastemanagementreview.com.au / WMR / 33
The DAF XF530 is ideal for delivery to sites with problematic access.
Resources reclaimed
NATIONAL RESOURCE RECOVERY
The hazardous waste space is an ever-changing environment. More than 70 classified types of hazardous waste were identified in the Hazardous Waste in Australia 2021 report, including contaminated soils and asbestos, wastes from chemicals and heavy manufacturing, and those from everyday sources such as oils, oily water, and grease traps.
Each of them requires specialised collection, transportation, and disposal to minimise the risk of environmental damage.
National Resource Recovery has been at the forefront of the hazardous waste industry across Melbourne since 1993 and continues to adapt to evolving community and regulatory expectations.

Sandro Accetta, General Manager of National Resource Recovery, says an increasing focus on governance and compliance means it’s crucial now, more than ever, for businesses to remain vigilant with their waste services.

“To comply with legislation and reduce the environmental impact of waste, every business in Melbourne needs an effective waste management solution,” Sandro says.
“At National Resource Recovery, we remain true to the cause and ensure hazardous waste is treated in the most cost-effective and compliant manner.
“Backed by a skilled group of people with almost 60 years of collective industry experience and knowledge, we pride ourselves on finding solutions for every challenge presented by customers.”
Sandro says National Resource Recovery understands the importance of reducing the amount of waste sent to landfill and offers recycling solutions across a range of sectors including business, industrial, manufacturing and domestic.
Recognised recycling services are available for oil filters, used rags, plastic and metal containers and aerosols. Where there isn’t a current path to reuse, the company will provide options to suit client circumstances such as business needs, size and work flows.
HAS BUILT A REPUTATION ON SOLUTIONSBASED HAZARDOUS WASTE TREATMENT. NOW IT’S LEVERAGING A GROWING DEMAND TO PUSH IT EVEN FURTHER.
FEATURED TOPIC – HAZARDOUS AND LIQUID WASTE 34 / WMR / August 2023
National Resource Recovery uses waste audits and waste management plans for solid and liquid waste solutions.
Sandro says that a growing push for green credentials and a move to a circular economy has driven an increased demand for recycling options. In response, National Resource Recovery
continues to seek out innovation and technology.
“We want to be the one provider that offers a full suite of hazardous waste services for all our customers,” he says.
“We want to take away the worry for our customers so they can focus on their day-to-day business objectives.”
A fleet of EPA Victoria-licensed vehicles collect and transport both liquid and solid waste streams to either National Resource Recovery’s fully licensed facility in Bayswater, Victoria or to an alternative EPA-licensed facility, where the wastes are sorted, treated, and where possible, repurposed.
National Resource Recovery was one of the forerunners to introduce an electronic tracking service for hazardous waste. Sandro says from the moment of collection, the company takes responsibility of the waste,


ensuring customers complete peace of mind. All wastes collected are documented and follow a full tracking system until treatment has taken place.
“That’s what’s important for us,” Sandro says. “Compliance and governance are the key. We will ensure we protect our customers and look after all their hazardous waste disposal challenges.”
Growth and expansion are high on National Resource Recovery’s agenda. Sandro says the company has built a reputation as a hazardous waste specialist and is keen to leverage that to attract a bigger market share.

“We want to become that one provider customers think of when they consider hazardous waste.”
For more information, visit: www.nationalresourcerecovery.com.au
Optimise compaction and increase productivity with Carlson machine guidance. Backed by industry expertise & nationwide support at Position Partners. 1300 867 266 • positionpartners.com.au WANT TO
SITE MORE EFFECTIVELY?
Used rags are collected, stored and sealed in metal containers to prevent spontaneous combustion.
MANAGE YOUR
Through no fire or flames
FIRE CAN QUICKLY DESTROY BUILDINGS OR INSTALLATIONS. WITH THEIR NON-CONTACT METHOD OF MEASURING TEMPERATURES, THERMAL IMAGING CAMERAS CAN HELP PREVENT FIRES BY DETECTING HOT SPOTS BEFORE THEY IGNITE

Any waste can potentially be flammable when stored, regardless of the substance. Fire hazards include self-combustion, heat development due to pressure, and spontaneous chemical reactions between disposals and methane gas-building. Thermal imaging cameras can help prevent fires by identifying hot spots with the potential to flare up.
Storing some materials at waste sites, warehouses, fuel piles, and similar locations invites the risk of spontaneous combustion. This can occur due to rising pressure or unseen reactions within the stored materials.

For example, some recycling facilities prefer to organise materials into “fluff” piles. These piles consist of combinations of cloth, plastic, metal, and rubber – all potentially saturated with oils. The
right mix of fluff, chemicals, and environmental conditions can spark quick-spreading fires.
Preventing such fires is not just a matter of personnel and environmental safety: it’s also one of economics. But most fire systems are designed to contain a fire once it starts – which isn’t always the most cost-effective solution. A system that allows companies to avoid fires or stop them in their tracks can save lives and money, and prevent downtime.
Fixed-mount thermal imaging cameras trained on the flammable materials can watch for temperature increases, catching the rising heat before the target combusts.
INFRARED VISION
Because these cameras rely on infrared
instead of visible light, this system can provide fire prevention coverage day or night, regardless of the lighting conditions. Many thermal camera systems provide rapid temperature data updates that can trigger alarms when the heat spikes dangerously, allowing companies to safeguard materials or turn off equipment that could cause or spread a fire.
FLIR A50 and A70 smart sensor cameras are ideal for users who want built-in, on-camera analytics and alarm capabilities for condition monitoring and early fire detection applications. With options for WiFi, an integrated visual camera, and ONVIF S compatibility (advanced version only), FLIR A50/A70 cameras are a flexible, configurable solution to meet the unique needs of
FEATURED TOPIC - FIRE MANAGEMENT 36 / WMR / August 2023
Storing some materials at waste sites, warehouses, fuel piles, and similar locations invites the risk of spontaneous combustion.
Infrared can provide fire prevention coverage day or night.
automation customers across a broad range of industries.
When used as a system component for cloud and Industrial Internet of Things (IIoT) solutions, A50/A70 cameras can help companies protect assets, improve safety, maximise uptime, and minimise maintenance costs.

FEATURES OF A50/70
The A50/A70 can quickly access thermal characteristics with the widearea, non-contact temperature sensor. The high-quality sensor is designed to provide up to 640 × 480 (307,200
pixels) resolution and ±2°C accuracy.
Teledyne FLIR has focused on simplifying integration efforts with smart thermal sensors. The A50/ A70 can communicate with standard industrial protocols and video management systems, including HMI, SCADA, and optional ONVIF S compatibility. The lightweight, IP66rated camera with M8/12 connectors can easily be installed in any location –with multiple mounting options.

DESIGNED FOR SAFETY
Designed for early fire detection and other condition monitoring solutions, the FLIR A50 Compact Smart Sensor Thermal Camera offers built-in, oncamera analytics and alarm capabilities. It also features internal software that can isolate regions of interest and report temperature ranges from those areas.
The Smart Sensor configuration means the A50 can perform the basic analysis to report temperature spikes. Thanks to ONVIF S compatibility, the A50 offers simultaneous VMS video and alarm integration. This compact camera
can fit anywhere at just 107 x 67 x 57 millimetre (4.21 x 2.64 x 2.24 inches). It has a rugged IP66 exterior to ensure it’s tough enough for harsh indoor or outdoor environments.
WHO IS TELEDYNE FLIR?
Teledyne FLIR designs, develops, manufactures, markets, and distributes technologies that enhance perception and awareness. It brings innovative sensing solutions into daily life through its thermal imaging, visible-light imaging, video analytics, measurement and diagnostic, and advanced threat detection systems.
Teledyne FLIR offers a diversified portfolio that serves several applications in government and defence, industrial, and commercial markets. Its products are being used to help first responders and military personnel protect and save lives, promote trade efficiency, and innovate consumerfacing technologies.
For more information, visit https://bit.ly/3NKghbo
www.wastemanagementreview.com.au / WMR / 37
The FLIR A50/A70 can quickly access thermal characteristics.
FLIR A50/A70 cameras are a flexible solution to meet the unique needs of customers across a range of industries.
Grinding in the Top End
WHEN HOME IS 700 KILOMETRES AWAY YOU NEED EQUIPMENT YOU CAN RELY ON. FOR PHIL SNELL’S GRINDING OPERATION IN THE NORTHERN TERRITORY, KOMATSU FOREST HELPS GET THINGS DONE.

Aremote location, the wrong equipment and monsoon rains – Phil Snell’s entry into the recycling/grinding industry was far from polished.
“It was quite challenging to get the job across the line,” Phil recalls. “Looking back now, we probably looked like hillbillies going into the bush.
“It was definitely a learning curve.”
Phil admits that 19 years ago he’d never heard of putting mulch or woodchip on a garden.
When a government contract to replace 100 kilometres of fence in the Northern Territory required the old timber to be mulched, he was out of his depth.
So much so, that for his first attempt he used a backhoe.
“It was quite unsuccessful,” Phil says with a chuckle.
The wet season may have beaten him back then, but Phil, the owner/operator of Snell Contracting and Hicway Pty Ltd, has found a home away from home in the red dirt of East Arnhem Land.
He built his business on land clearing and grinding green waste for local councils and has secured a five-year contract for site clearance and rehabilitation at Rio Tinto’s 15,000-hectare bauxite mining lease in Nhullaby, formerly Gove.
The Gove site has been supplying the global aluminium industry with bauxite
for more than 40 years but is expected to cease later this decade. Work to support closure of the operation and rehabilitate the area is already under way.
Phil and his team are clearing and mulching timber to be used to rehabilitate the mine’s burrow and red mud ponds.
“We delivered 80,000 cubic tonnes of soil enhancer last season,” Phil says.
“We’ve got to work around the wet season so we ramp things up where we can. We’ve got two grinders working 12 hours a day, seven days a week.”
Phil’s knowledge of the grinding industry has developed over the years, and he’s now quite discerning about having the right equipment for the job.
WASTE MANAGEMENT IN ACTION – GRINDERS 38 / WMR / August 2023
He purchased his first grinder, a secondhand Peterson 2400, direct from Jeffries Garden Soils in Adelaide.
Since 2016, he’s purchased five Astec/ Peterson 2710D Grinders, including two in September 2022, from Komatsu Forest, and is looking to upgrade to a bigger machine in 2024.

“The weather is harsh on everything here, so we don’t keep machines for very long,” Phil says. “We use them for 30004000 hours then move them on. We get good return on our investment then step into a new machine.”
Phil’s stuck with Komatsu Forest, and Peterson, because they’re focused on the timber industry and do it well.
Brenton Yon, Komatsu Forest National Sales Manager, says the Peterson 2710D is ideal for Phil’s operation because it’s designed for high production and frequent moves between jobs.
“It’s powerful, with a Caterpillar Tier II C18 765 hp (570 kW) engine for export, heavy duty and mobile, and has outstanding production throughput for a machine of this size,” Brenton says.
“The large feed opening, measuring 153 centimetres x 81 centimetres, is ideal for processing odd-sized feedstock and when boosted by Peterson’s high-lift feed roll, the feed opening’s maximum lift of 112 centimetres, is among the largest in its class.”
Brenton says the up-turn, threestage grinding process provides better fracturing of material and a consistent product, and the patented Impact Release System’s air bags provide uniform grinding and protection from contaminated feedstock, a feature unique to Peterson grinders.
Urethane cushions and shear pins offer a second line of defence, helping to protect the mill from catastrophic damage in the event of impact from contaminants in the feedstock.
Phil says Peterson machines have improved over the years, making a tough job, a little easier.
“There’s been huge development,” he says. “Those early machines were hard work. Even today, knowing what I do, I wouldn’t want to go back to some of those original machines.”
What has also developed over the years, is a relationship between Phil and Komatsu Forest.

Gove is the fourth-largest town in the Territory and a nine-hour drive from Katherine. For the Rio Tinto job, Phil’s equipment is transported by barge and remains onsite for six months.
The remoteness adds some complexity to servicing or any issues that arise, but Komatsu Forest “gets things to happen”.
“At the end of the day we’re a contractor and we have to make sure we deliver our jobs on time,” Phil says.
“Komatsu Forest have been true to their word.”
For more information, visit: www.komatsuforest.com.au
www.wastemanagementreview.com.au / WMR / 39
The Peterson 2710D is at home in the harsh conditions of the Northern Territory.
The Peterson 2710D is ideal for jobs requiring high production and frequent moves.
Not the standard fare
AS AUSTRALIA’S TRANSPORT SECTOR AIMS TO INTRODUCE MORE SUSTAINABLE PRACTICES, THE NEWLY BRANDED NATIONAL TRANSPORT RESEARCH ORGANISATION IS HELPING TO MOVE THE NEEDLE IN THE RIGHT DIRECTION.
Aculture of risk aversion, and an ad hoc adherence to procurement edicts still stand in the way of increased use of recycled materials within industry, says Dr Clarissa Han.
But the Chief Technology Leader/ National Leader, Sustainability and Materials Performance with the National Transport Research Organisation (NTRO – formerly the Australian Road Research Board), has seen a mind-shift over the past three to five years that is propelling Australia closer to a circular economy.

She’s optimistic that the use of recycled materials will soon be viewed as business as usual. Her work with NTRO is steering industry in the right direction.
“Our research and development aim to empower and educate the industry and ultimately benefit agencies and the broader community,” Clarissa says.
“Construction projects consume a large amount of virgin materials and with escalating pressure on decarbonisation and resource recovery; transport, road construction and maintenance are a great opportunity to divert waste.”
The Australian Road Research Board was established 60 years ago as a research and consulting service for Australian and New Zealand state road agencies and communities.
Today, it is a global leader, working with membership organisations and governments to develop specifications, trial new materials, and to understand market potential for the use of recycled products. A rebrand in June 2023 to the NTRO is aimed at offering a more integrated service for transport agencies.
Clarissa highlights that the domain of recycled roads represents a significant opportunity to introduce recycled products on a large scale. NTRO’s work in that area has grown with research focusing on a range of recycled materials such as crushed concrete and brick, recycled asphalt pavement
(RAP), glass, tyres, organics, residue ash and plastics.
“The NTRO Sustainability and Materials Performance (SMP) team has been heavily involved in implementing recycled materials into everyday use through laboratory testing, field trials and the development of specifications,” she says.
“These have included a specification for plastic noise walls, which is a performance-based specification that has facilitated the use of recycled plastic noise walls for Major Road Projects Victoria (MRPV) and a specification for recycled crushed glass sand for Austroads (ATS

WASTE MANAGEMENT IN ACTION – SUSTAINABILITY 40 / WMR / August 2023
Recycled glass, as shown in this road trial undertaken with Brimbank City Council in Melbourne, is one of the emerging materials for road construction that the NTRO is focusing on.
NTRO’s labs facility in Port Melbourne is used to conduct research on emerging materials, such as plastics, crushed concrete, and recycled carbon from waste tyres.
3050). The team has also undertaken the underpinning research to support the development of these specifications.
“The NTRO SMP team has recently validated and commercially trialled a new recovered carbon black product derived from waste tyres, which has shown to be an excellent candidate to substitute fine ground limestone filler performance and properties without the carbon impact of mining a natural material.”
Several projects recently delivered by NTRO are set to further influence the industry.
The Best Practice Advice on Recycled Material Use provides an independent review on how to successfully increase the use of recycled materials in road and rail infrastructure and examines 10 recycled materials for their potential use.
It also identifies the key barriers to using recycled products such as: low familiarity with product benefits and market opportunity; environmental regulation that is always behind; recycled product inconsistency across the nation; supply shortfall and capacity; and a lack of stable demand.
Based on environmental impact and greenhouse gas emissions, the best performed recycled materials are RAP and fly ash, used in road surface and base
layers as a replacement for asphalt. If you also consider economics, RAP is the most effective.
“Basically, an asphalt road can be 100 per cent recycled by using RAP,” Clarissa says.

A separate project, the Best Practice Advice on Recycled Material Use, 2022 Replacement Materials report, in collaboration with Infrastructure Australia, analysed the market potential of 998 road projects and how much virgin material can be replaced with recycled materials.
That report has identified the top five materials used in construction –aggregates, asphalt, blue or black stones, and cement – and 10 recycled materials that can be used to replace them.
Clarissa says the report found that about 27 per cent of conventional materials used for road projects could be replaced with a range of recycled materials. This would mean substituting about 54 million tonnes of conventional materials with about 52 million tonnes of recycled materials.
“If you push further, the blue-sky scenario is 59 per cent,” she says. “That means replacing 119 million tonnes of conventional materials with 114 million tonnes of recycled materials.
“Over the past decades many road agencies have been using recycled
materials for better outcomes in line with the National Waste Management Policy and action plan. Now some states are starting to introduce a buy recycled policy that prioritises recycled content; it’s a lot of effort and a significant change from risk aversion culture.
“Road engineers need a lot of confidence in the product they’re using. Many are gradually converting their attitude and we are playing a role in helping that, in terms of providing evidence and evaluation results. Everything we do here considers risk management and quality assurance.”
Clarissa joined ARRB 16 years ago as a research scientist. She says while every project is exciting, she’s enthusiastic about the emerging materials, such as recycled plastics and reclaimed carbon black, currently being studied and trialled.
“We continue to push the boundary and provide more opportunity for use of recycled content,” Clarissa says.
“NTRO is attracting a lot of attention nowadays. We’ve always conducted research, but it wasn’t as influential as it is now.”
For more information, visit: www.arrb.com.au
www.wastemanagementreview.com.au / WMR / 41
The NTRO has led the way in trials with recycled products in roads, including crumb rubber shown here in a trial for the Victorian Government in Bentleigh, Melbourne.
Switch it up
IT’S NOT JUST A NAME THAT ALLU MATERIAL PROCESSING BUCKETS SHARE WITH ONE OF THE MOST RECOGNISED MOVIE FRANCHISES.
Optimus Prime, the leader of the Transformer legacy, could easily have been speaking about ALLU buckets in his quote: “There’s more to them than meets the eye”.
The ALLU Transformer range converts a loader or excavator into a multi-function tool that will screen, crush, mix, load, aerate and pulverise waste.
They also transform waste materials into a new usable product, making processing jobs more efficient and environmentally friendly, while also minimising transport costs.
“Traditionally, contractors would load up a truck with demolition waste and dump it at landfill,” says Sami Rahman, ALLU Area Manager. “Now they’re thinking about how they deal with waste and how they can reuse it.

“Contractors are finding there is so much that can be recycled.”
ALLU buckets are purpose-built to process just about anything, including demolition and construction waste, excavated and waste soil, contaminated soil, clay, peat, bark, compost, and biowaste, all in one-step.
The processed material can be reused on site, reducing the need for virgin materials, or sold to generate extra income. Less material to landfill also means less expense in both landfill levies and transportation costs.
Sami cited disposal of construction waste in Victoria as an example of how cost-effective the ALLU transformer bucket could be.
The state’s waste levy rate for municipal and industrial waste has
increased from $44 per tonne in 2012 to the current $129.27 per tonne.
“It is common practice to remove fill from site, then to bring clean material back to achieve the required compaction,” he says.
“This means you’re paying $129.27/ tonne in disposal costs, $2 to $3 a kilometre to run a truck to the waste facility, then if you buy clean fill, you again pay $2 to $3 a kilometre to bring product back to your site. This also
WASTE MANAGEMENT IN ACTION – MATERIAL PROCESSING 42 / WMR / August 2023
ALLU buckets are purpose-built to process a range of wastes.
involves considerable use of valuable time on your project.
“Rather than allowing waste to become an increasing cost, you can use the ALLU Transformer bucket and process your existing fill on site.”

Sami says the buckets are designed and made to withstand the tough conditions of recycling and resource recovery. This is thanks to the steel used, while engineering ensures load distribution and screening systems don’t compromise the bucket’s integrity.
With a drum system, the material goes in and hits the walls of the bucket, that can cause structural damage.
“But with ALLU buckets, when material is screened, it rolls into the middle of the bucket and floats, rather than pushing material towards the walls of the bucket,” Sami says. “They last much longer than others. That’s where engineering comes into play.”
Manufactured in Finland, the ALLU Transformer range is among the widest spanning on the market, with units available to fit almost any base machine from the compact DL Series, that suit excavators from four to 12 tonnes, through to the M Series, which will fit excavators up to 160 tonnes and wheel loaders up to 90 tonnes.

ALLU has been sold in Australia for the past 20 years, but in 2018 the company established a national dealership network to provide better support and product supply.
ALLU machines and parts are in stock in Australia. Sami reports directly to the factory, so customer support is almost immediate.
“There are a lot of companies with a presence in the country but are not on
the ground,” Sami says. “I moved back to Australia at the end of 2018 from the Middle East because ALLU wanted to strengthen its Australian network.
“It’s very important to be able to support customers quickly.”
Taking the transformation theme to another level, the ALLU app is also transforming customer productivity, safety, and efficiency.
The app can notify customers about the need for maintenance or replacement of wear on parts, provides real time guidance of working angles and timely information about safe operations on jobsites.
All ALLU buckets have a sensor fitted to them. The ALLU app keeps track of a bucket’s working hours, cycle time, safety, and operating manuals.
“ALLU has a very big research and development department,” Sami says.
“It’s the only way we can keep up with the ever-evolving waste and recycling sector.”
For more information, visit: www.attachmentspecialists.com.au/allu or www.allu.net
www.wastemanagementreview.com.au / WMR / 43
Engineering and design ensure the ALLU buckets are structurally strong.
The ALLU bucket converts a loader or excavator into a multi-function tool.
Caterpillar redefines reliability
WITH CATERPILLAR’S EXPERIENCE IN TOUGH WORK ENVIRONMENTS, THE NEW 836 LANDFILL COMPACTOR BOOSTS MACHINE PERFORMANCE AND RELIABILITY.
The new Cat® 836 Landfill Compactor builds upon Caterpillar’s wealth of knowledge.

Upgrades to the axles and transmission have improved the longevity of the already robust main structures that endure multiple life cycles.
According to Bassem Ibrahim, Waste System Consultant for Caterpillar, this compactor also comes equipped with cutting-edge technologies. These tools enhance efficiency, allowing operators to meet compaction targets in fewer passes and save on fuel.
There are two configuration options for the Cat C18 engine powering the 836. Bassem says this allows the machine to meet local emissions regulation requirements around the world.
Improved radiator air inlet door sealing and a carry-over pressure hood enclosure help to reduce the need for engine compartment cleanout and facilitate maintenance planning as data captured alerts key personnel to the remaining service life of the engine air filter.
The new 836 compactor also has the Cat torque converter with a lock-up clutch. It eliminates torque converter losses while reducing system heat and delivering more power to the ground for improved traction.
“The advanced productivity electronic control system (APECS) transmission helps the compactor to achieve greater momentum on grades and achieves fuel savings by carrying momentum through shift points,” Bassem says.

ADVANCED COMPACTION
Cat Compact technologies integrate advanced compaction measurement, in-cab guidance, and reporting. Fuel is saved as compaction targets are met with fewer passes. The system includes a global navigation satellite system (GNSS) receiver atop the 836 and a mapping display inside the cab.
The standard Cat Compact with Pass Mapping provides accurate
pass counting, enabling operators to monitor coverage areas and the number of passes on the 10-inch (254-millimetre) display. Optional Compact Elevation Mapping combines pass counting with elevation monitoring of slopes, allowing for precise layer thickness planning, control, and improved density.
“Visualised remotely through VisionLink, standard Cat Link technology grants access to machine location, hours, fuel consumption, idle time, events, and diagnostic codes,” says Bassem. “Operators stay informed about operating conditions via a 3G touchscreen with a user-friendly interface for viewing vital information management systems (VIMS) data.”
WASTE MANAGEMENT IN ACTION - MACHINERY 44 / WMR / August 2023
The Cat 836 Landfill Compactor can handle any terrain while dealing with
RUGGED RELIABILITY







The new Cat 836 boasts larger diameter shafts and Cat locker differentials, enhancing the drive system’s longevity, improving direction shift speed, and increasing traction in the waste stream.
Updates to the final drive gear set reduce stress and enhance the gear’s pitting life while a new fan motor guard prevents bag wrapping, and a five-inch (127-millimetre) fuel filter ensures cleaner fuel reaches the engine.
“Service and inspection have been made effortless with the new compactor, prioritising safety by providing ground-level or platform
Increased guarding around the axles mitigates the risk of component damage.
“Leveraging VIMS data enables operators and technicians to address machine issues before they result in failure”.

EFFICIENT PERFORMANCE
The upgraded operator’s environment in the 836 includes a lowered glass design and pressurised, climate controlled cab that maintains low interior sound levels at 72 dBA.
The design offers improved
LEEF SYSTEM®


consolidates steering, gear selection, and other functions into a single lever for maximum responsiveness, control, and reduced operator fatigue.
Bassem says the new 836 is designed for landfill compaction and offers five-wheel and tip configurations to optimise compaction. The lighter paddle tip design delivers high performance and traction with minimal fuel consumption, while the plus tip traditional design enhances stability on side slopes.
“Caterpillar’s exclusive diamond tip wheel provides the longest tip life in
Pioneering PFAS Removal from Wastewater 1800 42 62 62 | enquiry@waterandcarbon.com.au
treament solution Direct PFAS Removal from Leachate Without Pre-Treatment Eliminates Need for Consumables Removal Below Limit of Detection Low Energy and Operational Requirements Flexible Treatment Capacities Low Volume Waste Stream Modular, Scalable and Adaptable waterandcarbon.com.au Chat to us today!
PFAS
Tail’s end
ASHARA MOORE CLAIMED THE EXCELLENCE IN MINING AWARD, SPONSORED BY WEIR MINERALS, AT THE 2023 WOMEN IN INDUSTRY AWARDS. SHE SHARES HER JOURNEY FROM A YOUNG WOMAN AGAINST MINING TO A PHD STUDENT RESEARCHING SUSTAINABLE SOLUTIONS FOR TAILINGS WASTE.

 BHP’S
BHP’S
When she first stepped onto a mine site, it was the management of tailings that left the most lasting impression on Ashara Moore.
She was told that, generally speaking, tailings waste is stored in large dams over time, and that was that.
Ashara says she remembers, as an undergraduate student, thinking that this couldn’t be the only way. But her time constructing tailings facilities in the years that followed across numerous mine sites Australia-wide, reaffirmed that it was the norm.
It was through talks about her experience with her now supervisor at Queensland University of Technology, alongside an interest in her team’s work in the High Purity Alumina (HPA) space, that she landed on a topic for her PhD.
A year and a half into her study, Ashara aims to invent a soil amelioration technique using enhanced weathering and other soil amendments to stabilise acidic soils, sequester carbon dioxide, and provide material that is suitable for rehabilitation purpose.
If successful, Ashara will be providing a new type of carbon reduction technology (CRT) that could positively impact mining’s green-house gas emission targets. It would also provide a more sustainable solution to the management of mineral processing tailings.

It’s a big turnaround for someone who once brazenly admitted during a work experience interview with Rio Tinto that she was morally opposed to mining.
To her surprise she got the gig and within a few months found herself onsite at Kestrel Coal Mine in Emerald, Queensland.
“It was a turning point for me,” Ashara says. “I had a unique opportunity that many aren’t afforded; the opportunity to be exposed, utterly, to the mining industry. It was there that I began to understand that a world without mining is a world that is unable to obtain critical resources, and a world without critical resources means a world without renewable energy, innovative technology, and improved standards of living.
“I was directly exposed to the legislation and policy that governs the sector, and the growing push toward better environmental, social, and governance (ESG) outcomes. It not only made me appreciate that this was an
industry trying to do and be better, but it was a sector that I thought I could make a positive difference within.
“Luckily, my pre-conceived ideas at the time did not preclude me from a commencing a worthwhile and rewarding career.”
The processing required to extract most ore types often result in hazardous, acidic waste. This is particularly harmful if released inadvertently to the environment. Ashara’s interested in how the various elements in that waste can interact with the surrounding soils and groundwaters.
“I am not of the opinion that mining can simply cease – how else could we possible retrieve the critical minerals needed for renewable technology and all the other magnificent things that we rely on in our daily lives,” she says “I am
EVENTS
Ashara Moore is studying alternative methods to deal with mining waste.
46 / WMR / August 2023
Ashara Moore collects her award at the 2023 Women in Industry Awards.
pro finding solutions to ensuring that our sector can peacefully co-exist with our environment. Tailings management (currently) is the avenue in which I wish to play my part in this venture.”
Currently, a tailings storage facility (TSF) is the primary method of waste management within the mining industry. The most common and well-known is tailings dams.



Ashara says storage in such facilities generally involves deposit of tailings slurries, which are transported post-processing (to separate ore) from preparation plants into large dams purpose-built to store waste material. Over time, they are filled, decommissioned, and then rehabilitated.
The driving consideration behind tailings dam designs is that they are to be designed in perpetuity – to remain for life without human interference. This
essentially means that waste material is stored for the foreseeable future; it is not remediated.




Ashara hopes that the resources sector will find new ways to extract critical minerals, while ensuring the planet’s longevity for future generations.
“My PhD study is just one very small, very niche segue toward achieving that goal,” she says. “By targeting mining waste, one of the most substantial potential environmental impactors within industry, and hopefully finding more sustainable and responsible ways of managing this waste, I hope to contribute to the ESG agenda gaining momentum in the sector.
“In doing so, I am hoping to achieve a new ‘normal’ about the way we think about tailings waste. I hope that in future conversations for businesses, we are considering remediation as a

potential waste management tool, rather than storage.”

She says the greatest barriers to her work are commercial viability– it would be fantastic to land on a solution for remediating tailings waste, but it will hold little value in industry if it can’t be made economically advantageous to businesses – and the inadvertent carbon output of her work.
“As with the universe, it’s all a balancing act to reach equilibrium.”
Ashara is starting laboratory work to understand the tailings waste she’s focusing on during her study and assessing its potential impact on the environment if stored using contemporary methods.
In August she presented her preliminary findings to the World Chemistry Conference in the Hague, Netherlands.
2023
INTRODUCING 3 NEW MODELS TO THE OUTSTANDING SDLG WHEEL LOADER RANGE: H-SERIES WHEEL LOADERS
11-tonne L936HLA & L938H, and 13-tonne L946H Spacious air-conditioned cab with a wraparound pillarless windscreen 3 year / 6000 hour warranty on all new SDLG machinery
SDLG IS A MEMBER OF THE VOLVO GROUP View here FIND YOUR LOCAL CJD EQUIPMENT BRANCH FOR MORE INFORMATION CJD.COM.AU | 1300 139 804
NEW RANGE New
High torque, fuel efficient Weichai
6
cylinder engine
Waste watchdogs
FOUR KEY REGULATORS IN VICTORIA’S WASTE AND RECYCLING SECTOR WILL PROVIDE AN OVERSIGHT OF THE STATE’S JOURNEY TO A CIRCULAR ECONOMY AT WASTE EXPO 2023.
It’s the biggest question in Victoria’s waste and resource recovery sector right now, and one that the Victorian Waste Management Association (VWMA) wants answered – how do the state’s industry regulators and authorities come together, and is it working?
Four of Victoria’s industry figureheads will join a panel discussion at the VWMA industry breakfast, to be held on day one of Waste Expo Australia 2023. Lee Miezis, Chief Executive Officer of Victoria’s Environment Protection Authority (EPA), Tony Circelli, Head of Recycling Victoria, and Matt Genever, interim Chief Executive Officer of Sustainability Victoria, will take to the stage with Sebastian Chapman, Executive Director Waste and Recycling for the Department of Environment, Land, Water and Planning.
Brett Lemin, VWMA Executive Officer, says it’s a unique opportunity to hear from
four key decision makers on what is a trending topic.
“With the introduction of Recycling Victoria adding an additional regulator into the state’s sector last year, there are still a lot of questions around how authorities are working together,” Brett says.
“How does the framework exist in reality? If someone has an issue and it’s EPA regulated, how does it flow through Recycling Victoria or Sustainability Victoria? If Recycling Victoria notices an area in the market that needs priority, what happens in the background? Are all the necessary bodies communicating?
“Twelve months down the track, this is an opportunity to find out where they all sit.”
VWMA hosts four industry breakfasts each year. Brett says combining a breakfast with Waste Expo Australia is an ideal platform to engage the industry.
“The expo is shaping up to be another terrific event and a great way to expose people outside of the association to what it does and why,” he says.
“It’s about creating the opportunity and awareness that will bring more people to the market.”
NATIONAL EXPOSURE
A free-to-attend event, Waste Expo Australia is dedicated to advancing best practices in waste management and making a positive difference to the environment and community.

It’s billed as the largest gathering of waste management and resource recovery professionals from a broad industry base, including waste services, consultancy, material recovery facilities, manufacturing and transport and logistics.
Often described as the gateway to decision-makers within the waste, recycling
EVENTS 48 / WMR / August 2023
and resource recovery sector, the expo will look at the big issues – circular economy, waste-to-energy, commercial and industrial waste, and organics – among others.
The two-day conference program, chaired by sustainability advocate Sally Williams, will include 60 sessions across four stages and involve more than 100 industry speakers.
The exhibition floor will also feature more than 100 equipment and technology suppliers.
INNOVATIONS
Among them will be engineering and manufacturing company Wastech which has secured the Australian and New Zealand rights to sell the Fire Rover fire suppression unit.
The Fire Rover includes advanced thermal cameras, equipped to detect even the slightest rise in temperature, combined with smoke and flame analytics. It has won multiple industry awards, including the innovation product and tech award at the 2022 Fire Protection Industry Awards, and Wastech is keen to bring a unit to the expo.
It’s an auspicious introduction to the Australian market, with a reduction in the number of insurers willing to insure waste management companies and an increasing
incidence of fires at facilities.
Clete Elm, Chief Executive Officer for Wastech, says the expo is a valuable opportunity for businesses in the waste and recycling sector.
“It’s vitally important to get feedback from the market in terms of what they’re looking for, but also for us to educate the market about new solutions,” Clete says.
Bucher Municipal is another exhibitor bringing new solutions to the market with a hydrogen powered waste truck in collaboration with Pure Hydrogen.
Waste Expo Australia 2023 will be held from 25-26 October at the Melbourne Convention and Exhibition Centre.



The Industry Breakfast and panel discussion will be held from 7am on day one, Wednesday 25 October.
The expo is co-located with AllEnergy Australia and will be held in partnership with the Waste Innovation and Recycling Awards.
For more information, visit: www.wasteexpoaustralia.com.au
www.wastemanagementreview.com.au / WMR / 49
The exhibition floor will feature more than 100 equipment and technology suppliers.
The Waste Expo conference sessions always attract large attendances.











Melbourne Convention and Exhibition Centre 20-21 Sept 2023 CONFERENCE SPONSORS ASSOCIATION PARTNERS SUPPORTING SPONSOR EXHIBITION SPACE NOW ON SALE Melbourne’s leading construction and major infrastructure event insideconstructionexpo.com.au Get your share of major infrastructure projects
Building momentum

WASTE MANAGEMENT REVIEW GOES BEHIND THE SCENES OF THE INAUGURAL 2023 INSIDE CONSTRUCTION EXPO.
Sustainability is set to gain importance as Australia strives to reach its circular economy ambitions. Melbourne’s premier construction and infrastructure event, Inside Construction Expo 2023, will amplify the transformation.

Dedicated to commercial and civil projects in the Australian construction industry, Inside Construction Expo is being held from 20 to 21 September 2023 at the Melbourne Convention and Exhibition Centre.

The expo will feature a robust conference program involving top-level speakers, a world-class exhibition of equipment and technology, and the Inside Construction Foundation Awards.
With multiple stages across the event focusing on sustainability, health, safety and wellbeing; training, education and careers; digital transformation and connectivity; and construction productivity, there will be a wealth of industry information and solutions.
Show Director Lauren Winterbottom says the event will be a platform to
showcase successful sustainability outcomes and make new connections.
“Attendees can expect to hear from executive-level representatives on topics including the role of circular economy, carbon reductions in the built environment, use of sustainable materials and designing for sustainable future,” says Lauren.
Speakers will include Nick Alsop, Senior Manager Buildings Precincts and Homes, Green Building Council. Nick has extensive experience in sustainable urban design and planning, environmental management, renewable energy deployment and property sector support programs.
Clare Tubolets, is Chief Executive Officer at SmartCrete CRC, a Commonwealth funded Cooperative Research Centre focused on empowering research collaboration to support concrete sustainability and viability in Australia.
After 15 years working across state and Commonwealth government, Owen Buckley joined the Infrastructure Sustainability Council in June 2022 in
the role of General Manager, Ratings and Delivery. He brings experience in the public sector across interpretation and application of legislation and international stakeholder relationship building.
Jason Zarifiadis, Carbon Innovation Executive, TSA Management, most recently he led the international scale up and commercialisation of the world’s only zero-cement concrete.
Inside Construction Expo is backed by valued organisations and media partners.
“We’re pleased to partner with industry associations and peak bodies, along with leading commercial businesses, to bring Inside Construction Expo to life,” Lauren says. “Specialist in assembly and fastening materials, Wurth Australia has come on board as a supporting sponsor for the Expo.”
Serge Oppedisano, Chief Executive Officer of Wurth Australia, says 2023 Inside Construction Expo, promises to be a game-changer for the industry.
Intelligent positioning solutions provider Position Partners and manufacturer Komatsu are also conference sponsors.
Association partners include The National Association of Women in Construction; The Working at Height Association of Australia; The Concrete Pumping Association of Australia; The Institute of Quarrying Australia; The Crane Industry Council of Australia; The Formwork Industry Association; Landscaping Victoria Master Landscapers; and The Piling and Foundation Specialists Federation.
For more information, visit www.insideconstructionexpo.com.au

EVENTS – INSIDE CONSTRUCTION EXPO www.wastemanagementreview.com.au / WMR / 51
Inside Construction Expo will feature several speakers focusing on sustainability in the industry.
Kicking goals
EARLIER THIS YEAR, BAYSIDE COUNCIL, NEW SOUTH WALES, ADDED THE 2023 NATIONAL AWARD FOR LOCAL GOVERNMENT IN THE WASTE MANAGEMENT CATEGORY TO A GROWING LIST OF ACCOLADES. MAYOR, DR CHRISTINA CURRY, SHARES THE COUNCIL’S CIRCULAR ECONOMY SUCCESS STORY.
The National Awards for Local Government are an annual celebration of local governments that implement initiatives that make a difference to their communities.
In June, Bayside Council won the waste management category, beating 537 councils Australia-wide.
Mayor, Dr Christina Curry, says the award is recognition of the progress the council is making in implementing a circular economy.
“Reducing waste is a very high priority for our community and we’re pleased that Bayside Council has been recognised for the progress we are making,” Christina says.

“Our residents are very proud of our beautiful Bayside area and this recognition gives them further endorsement that they live in a great area.
“It’s also a significant achievement and acknowledgment of all the hard work that staff have put in over a long period of time. It gives us additional motivation to keep focused, inspired, and motivated on what we are trying to achieve.”
In 2018, Bayside designed and introduced the Waste Avoidance and Resource Recovery Strategy (WARR) 2030 with a focus on shifting away from the traditional status quo linear economy of take, make, use, and dispose.
Christina says studies at the time indicated that the council’s landfill would be full by 2030, and so the goal was to achieve a circular economy model that anticipates, designs, procures, and promotes for resources to be either safely
returned to nature or back into systems where they can be reused or renewed.
“This new model would be less reliant on burying items that are a valuable resource,” she says.
“Bayside Council’s vision is to be an environmental leader. This includes working with residents and commercial businesses in the region to avoid waste and maximise recovery of resources through the actions outlined in this WARR Strategy 2030 and associated action plans to promote responsible citizenship.”
Bayside Council’s circular economy strategy has resulted in many achievements including mandating the use of recycled material in the council’s annual road re-sheeting program, up to 18,000 tonnes of organic material is extracted annually from Bayside’s general waste bins at an advanced
treatment facility and used as compost to rehabilitate an old mine site and 22 annual community recycling drop-off events for materials such as mattresses, expanded polystyrene, tyres, and bicycles have been held, resulting in more than 160,000 kilograms of waste diverted from landfill per annum.
Smart, solar-powered mobile surveillance trailers and interactive education mobile vans have assisted in reducing illegal dumping incidences by 10 per cent, and weight of material by 27 per cent per capita. Implementing 80 ‘smart sensor’ beach litter bins over eight kilometres of beachfront has prevented 60,000 kilograms per annum of litter from entering waterways and pollution control devices have helped divert 225,000 kilograms of unwanted material annually from entering waterways.
COUNCIL IN FOCUS 52 / WMR / August 2023
Bayside Council’s Dr Christina Curry, Hong Nguyen, Patricia Chamberlain, Joe Logiacco and Colin Clissold accept the 2023 National Award for Local Government, waste management category.
The strategy has resulted in 13 state environmental awards for the council. Christina attributes the success to a clear vision and a shared sense of purpose.
“We have a clear roadmap and have taken our community with us on our circular economy journey, constantly engaging, and promoting new initiatives and innovations,” she says.
In 2019, Bayside was the first council in New South Wales to trial Reconophalt AC14, an asphalt product designed for heavy use that incorporates recycled materials. It was laid at the Bayside Operations Depot in Bexley that is constantly traversed by heavy fleet, plant, and equipment.
Christina says the work at the depot involved laying nearly 400 tonnes of new asphalt containing recycled material equivalent to 314,558 plastic bags, 25,882 glass bottles and 7142 toner cartridges.
“This roadway has held up extremely well and was our starting point in using recycled material in our road re-sheeting program,” Christina says.
Following the success of the Reconophalt trial, Bayside formed part of a Southern Sydney Regional Organisation of Councils (SSROC) “Paving the Way” initiative to mandate the use of crushed recycled glass into regional and local road re-sheeting programs.
At the time, there was a nationwide issue with the stockpiling of glass that was not been recycled. In its first year, Bayside used 600 tonnes of recycled crush glass (equivalent to three million glass bottles) and 4500 tonnes of recycled asphalt in its re-sheeting program.
In June 2023, the council began trialling the use of recycled rubber from end-of-life car and truck tyres in the asphalt mix on one of its roads. An initial 3600 standard passenger car tyres, or 2400 car and 490 truck tyres combined, will be used in the crumbed rubber asphalt trial project, involving 12 councils in the region.
The performance of each asphalt mix will be monitored over an initial 12-month period.
Christina says the project will generate comprehensive data on the use of recycled rubber-based treatments on local roads and is expected to contribute to the development of crumb rubber asphalt specifications in future projects.
And she says it doesn’t stop there. Bayside will continue to investigate, innovate, and implement initiatives and embrace emerging technologies to achieve its vision and targets.
In 2022, the council created a new Environment and Resilience business unit to address matters such as climate change, biodiversity, and sustainability and this year will update its WARR Strategy to include and align key strategies, initiatives and targets as detailed in the NSW Waste and Sustainable Materials Strategy 2041.

Christina says anecdotal evidence points to the strategy and awards adding to the sense of pride residents have for the area.
She says face-to-face and social media engagement is always high when the
council discusses sustainable waste initiatives or recognises significant milestones and achievements.
And for other council areas looking to introduce circular economy strategies, she has these words of advice:
“A circular economy strategy should be an over-arching roadmap that sets a council’s long-term vision and aspirational targets.
“The annual action plans need clear milestones. They have Specific, Measurable, Achievable, Relevant and Time-bound (SMART) milestones or steps on that circular economy journey. This is a life-time commitment to doing better every year.
“We learnt early on our circular economy journey that we must constantly improve, be agile and adapt to environmental and market conditions. This was particularly important in recent times, dealing with extenuating circumstances such as the COVID-19 pandemic, global supply chain issues, and natural disasters, where our community and our business continuity and contingency plans were tested.”
www.wastemanagementreview.com.au / WMR / 53
Bayside Council’s circular economy and waste management strategy has claimed several awards.
TUTT BRYANT, BOMAG BC1173RB-5 LANDFILL COMPACTORS
Five BOMAG BC1173 RB-5 Landfill Compactors, known as the King of the Mountain, will arrive soon on Australian soil to their respective clients.
The new BC1173 RB-5 is establishing itself as the go-to landfill compactor because of its safety, operator comfort and ergonomics, easy maintenance, and compaction performance.
BOMAG BC1173RB-5 Landfill Compactors are available as Tier 3 or Stage V and are designed specifically for the optimal compaction required by large municipal waste facilities.

The BC1173 RB-5 uses polygon disc wheels fitted with premium teeth – with a wear warranty of 10,000 working hours (pro rata) – for crushing, kneading and effective compaction to depth. An oscillating articulation joint provides good load distribution to the compaction wheels, while scrapers and wire cutters guarantee clean wheels during operation.
APPLIED MACHINERY, GENOX BH SERIES SHREDDERS
The Genox BH “Behemoth” Series Single Shaft Shredders are heavy duty, reduction machines specifically designed for shredding a wide variety of untreated waste material streams down into either coarse or medium-sized fractions.

The powerful, wear-resistant machine structure is well suited to demanding recycling tasks.
All BH series models feature a force-feeding ram, a high-performance rotor, classifier screen and hydraulic
power unit. Six models are available to cater to a multitude of different applications.
The BH series complements existing Genox Vision, Xeno and Mino series’ of shredders, and the GranCalibur series granulators which offer defined size reduction of various materials in a single pass.
54 / WMR / August 2023
Contact – Applied Machinery P 03 9706 8066 E sales@appliedmachinery.com.au W www.appliedmachinery.com.au PRODUCT SPOTLIGHT Contact – John Glossat M 0407 283 164 W www.tuttbryant.com.au E John.Glossat@tuttbryant.com.au
MATERIAL PROCESSING BUCKET – D-SERIES
The ALLU D-series of hydraulic screening buckets for excavators and loaders are purpose-built for efficient material processing by screening, crushing, aerating, mixing, separating, feeding, and loading materials onsite in a one-step operation.
By reducing the number of process steps needed and transforming waste into usable material, ALLU D-series buckets make processing jobs more efficient and environmentally friendly and minimise the need for transportation of waste and replacement materials. This results in substantial savings in material, time, and transport costs.
ALLU D-series buckets are ideal for a variety of large material processing and handling tasks, from topsoil screening to utility and road works, construction waste and asphalt recycling and pipeline backfilling.
ALLU performance can be measured with ALLU Sensor that records bucket count, processing time, total working time and processed tonnes.
ALLU D-series buckets suit excavators from 10 to 45 tonne and wheel loaders from 4 to 30 tonne.

The Komptech Topturn 5000 is an advanced and efficient compost turner designed for large-scale composting operations. With its robust construction and powerful performance, the Topturn 5000 can process vast quantities of organic waste materials, helping to accelerate the composting process and produce highquality compost.
Equipped with a powerful engine and a sophisticated turning mechanism, the Topturn 5000 can mix and aerate the compost piles, promoting proper decomposition and preventing the formation of anaerobic conditions. Its large turning capacity enables it to handle substantial amounts of material, making it ideal for industrial-scale composting facilities.
The machine’s advanced technology allows for precise control and monitoring of the composting process, ensuring optimal conditions for microbial activity and facilitating the production of nutrientrich compost.
The Topturn 5000 is also designed with operator convenience in mind, featuring a user-friendly interface and ergonomic controls.

www.wastemanagementreview.com.au / WMR / 55
KOMPTECH CEA, KOMPTECH TOPTURN 5000 COMPOST TURNER
Contact – Komptech CEA P 1300 788 757 W www.komptechcea.com.au E marketadmin@cea.net.au PRODUCT SPOTLIGHT Contact –
Network W www.attachmentspecialists.com.au
ALLU
ALLU Australian Dealer






Recognising excellence across the waste, resource recovery and recycling sectors. 2023 NOMINATIONS ARE NOW OPEN www.wasteawards.com.au/nominations To nominate visit 25 OCTOBER 2023 SPONSORS HELD IN CONJUNCTION WITH
Drawing fire
From flames to fame… and not the good type! Untamed stockpiles and facility fires have plagued the waste industry’s reputation over the past few years, rocking the public perception of the industry, putting regulators on edge, and wreaking havoc on the insurability of the industry.

The severity and frequency of these fires have not only shaken the regulators within the space we operate but have also dealt a blow to the industry’s social license to operate. This is excluding the battery fire issue, which is a different discussion altogether.
For those familiar with my previous articles and presentations, it comes as no surprise that I’m a strong advocate for collaboration and education among
all stakeholders. It is through this collective effort that we can drive real change and transition towards a more sustainable future.
When we reflect on the past and the series of incidents that triggered regulatory changes in Victoria, one thing becomes abundantly clear – not everyone is effectively managing their fire risks. Whether it is due to negligence, ignorance, or illegal profiteering, we can leave that to water cooler speculation. However, one thing remains unclear: whether business owners and their employees possess the necessary resources and training to handle the relevant goods and fulfil their legal obligations.
While there are plenty of informative resources and training courses available
for the storage and handling of dangerous goods and the ADG Code, the same cannot be said for the more generic combustible materials that the waste industry handles.

In response to this gap, a few years ago the Victorian Environment Protection Authority (EPA), in collaboration with Fire Rescue Victoria and the Country Fire Authority, produced Guideline 1667, also known as the Management and Storage of Combustible Recyclable and Waste Materials guideline (CRWM), now in its third edition.
The CRWM is a valuable resource that covers the fundamentals of identifying and assessing combustible risks within a facility, as well as the essentials of incident planning and management. It
VICTORIAN WASTE MANAGEMENT ASSOCIATION EXECUTIVE OFFICER BRETT LEMIN TALKS ABOUT THE IMPORTANCE OF INDUSTRY BEING AWARE OF ITS OBLIGATIONS AND EQUIPPED WITH THE KNOWLEDGE TO PREVENT FACTORY FIRES.
LAST WORD www.wastemanagementreview.com.au / WMR / 57
VWMA has partnered with Circular Resources Australia to provide a training program to help waste industry operators reduce fire risks.
contains plenty of useful and relevant information. However, it is unlikely that every employee will be able to read and comprehend a technical 80-page resource that mentions “risk” a staggering 276 times, let alone retain all the information contained within. Nevertheless, it remains crucial that they grasp the document’s contents.
So how can the industry, ensure that everyone is aware of their obligations and equipped with the knowledge to prevent further mismanagement and factory fires? One approach is to provide high-quality training delivered by knowledgeable professionals in an informative and accessible manner.

In 2018, the Victorian Waste Management Association (VWMA) partnered with EPA Vic to develop a training course centred around stockpile management and the information presented in the CRWM guideline.
This course was intentionally designed to be interactive, encouraging participants to share experiences and real-life incidents. By working together, they delve into the course material, fostering a learning process that combines hands-on activities, active listening, practical interaction and it doesn’t hurt to inject a little bit of fun into the process.
With the EPA’s support, the VWMA successfully delivered this course free of charge to more than 100 individuals within the waste and recycling industry. The feedback has been positive, with many participants implementing changes within their operations. Moreover, an eagerness for more in-depth training within this field has been ignited.
In response, the VWMA has partnered with the team from Circular Resources Australia (CRAUS) to revamp the training program. This endeavour aims to encompass additional information and extend beyond the confines of the original CRWM guideline. If you’re interested, you’ll have the opportunity to engage with the CRAUS and EPA as they present at Waste Expo 2023.
The collaboration between the EPA Vic, VWMA and CRAUS is a promising step forward in addressing the issues of mismanagement and preventing future fires.
By expanding the training program to cover a wider range of resources and incorporating insights from industry, participants will have access to a more comprehensive understanding of stockpile management and the safe handling of combustible materials such as understanding the ignition and burn temperatures of materials on site.
It’s important to recognise that the responsibility for preventing fires and ensuring safe waste management practices does not lie solely with regulators. It is a collective effort that requires engagement from regulators, business owners, employees, and relevant stakeholders. By fostering a culture of learning and improvement, individuals within the industry can be empowered to make informed decisions and take appropriate actions to mitigate risks.
In addition to the training initiatives, it’s crucial for regulators to not only enforce strict regulations but also provide support and resources to businesses to help them comply. This includes conducting regular inspections, offering guidance on best practices, and facilitating knowledge-sharing platforms where industry professionals can exchange insights and experiences.
Ultimately, the journey to best practice requires a concerted effort from all stakeholders involved in the waste industry. It demands a commitment to collaboration, education, and continuous improvement. By investing in quality training, promoting knowledge exchange, and strengthening regulatory frameworks, we can rebuild public trust, enhance safety standards, and pave the way for a more sustainable waste management sector.
For more information, visit: www.vwma.com.au
58 / WMR / August 2023 LAST WORD
Brett Lemin, Executive Officer, Victorian Waste Management Association
“By investing in quality training, promoting knowledge exchange, and strengthening regulatory frameworks, we can rebuild public trust, enhance safety standards, and pave the way for a more sustainable waste management sector..”
Brett Lemin Executive Officer, Victorian Waste Management Association






We love what we do
Right across Australia, REMONDIS supports 24,000 commercial and industrial customers to meet their waste collection, processing, recycling and circular economy ambitions. Since 1982 we’ve grown to 1,100 employees across 39 branches from Gladstone to Wingfield, Henderson to Seven Hills. We have the scale and expertise – both local and global – to make a difference and, best of all, we love what we do.

T 13 73 73 // remondis-australia.com.au

BHP’S
BHP’S

































